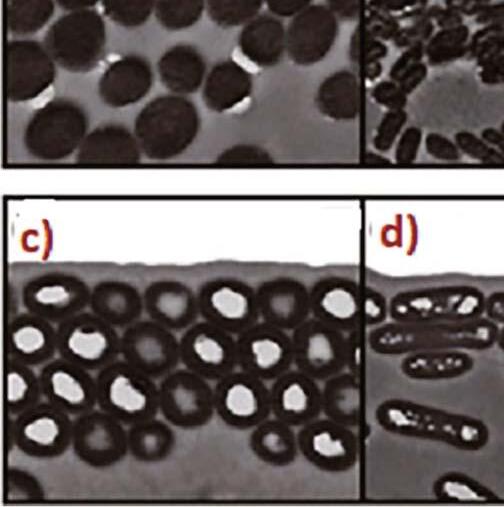

ANNO LI
numero 11/12 2025
















![]()

ANNO LI
numero 11/12 2025


















sulla




AMMINISTRAZIONE E PUBBLICITÀ: Segreteria F.O.I.-Onlus Via Caorsana, 94 - Località Le Mose 29122 Piacenza
Tel. 0523.593403 - Fax 0523.571613
Web: www.foi.it - E-mail: redazione@foi.it
Direttore Responsabile: Antonio Sposito Caporedattore: Gennaro Iannuccilli
Collaboratori di Redazione: Giovanni Canali, Maurizio Manzoni, Francesco Rossini
Commissione Salute, Benessere animale e Ricerca Scientifica: Elena Circella, Giuseppe Marruchella, Gianluca Todisco
Coadiutore Editoriale: Lorenza Cattalani

Associato all’Unione Stampa Periodica Italiana ISSN 0391-254X (International Standard Serial Number)
Autorizzazione del Tribunale di Bologna n. 4396 del 12-3-1975
Stampa: MEDIAGRAF S.p.A.
Viale della Navigazione Interna, 89 35027 Noventa Padovana (PD) - Tel. 049 8991 511
Inoltro postale in Italia: MEDIAGRAF S.p.A.
ABBONAMENTI ANNUI:
Italia € 30,00 - Estero-Europa € 50,00
Estero-ExtraEuropa € 70,00
Un numero € 5,00 - Arretrato € 6,50
C.C.P. 53684957
Le quote abbonamento vanno versate, mediante vaglia o assegno, alla Segreteria. Le opinioni espresse dagli Autori non impegnano la Rivista e la sua Direzione.
La Redazione si riserva il diritto di non pubblicare o emendare gli articoli proposti. I collaboratori assumono piena responsabilità delle affermazioni e delle immagini contenute nei loro scritti. Vietata la riproduzione, anche parziale, se non espressamente autorizzata. © F.O.I. In copertina: Parrocchetto dal collare indiano - femmina Viola (Psittacula krameri manillensis) Foto: PHILIPPE ROCHER









testo e foto di F RANCESCO BADALAMENTI
In ambito associativo il senso di appartenenza si riferisce a quel sentimento di identificazione, a quel legame emotivo che il singolo sviluppa, sentendosi parte di un’organizzazione, condividendone obiettivi, valori e missione. In sintesi, per senso di appartenenza si intende l’attaccamento che il tesserato ha verso l’Associazione/Federazione cui ha deciso di aderire, per la condivisione di progetti comuni e di obiettivi da raggiungere anche attraverso il proprio contributo all’interno del gruppo. È un concetto centrale per il buon funzionamento di qualsiasi gruppo, organizzazione o ente associativo. In questo contesto il logo gioca un ruolo importantissimo nel rafforzare e consolidare questo spirito di appartenenza, fungendo da simbolo visivo che rappresenta l’identità associativa; inoltre l’elaborazione di un acronimo che prevede l’uso di un “lettering” ben preciso e di uno slogan efficace, che - nel nostro caso - è “Allevare è proteggere”, rappresentano l’elemento chiave dell’identità del gruppo e servono per aiutare il pubblico esterno a riconoscere l’organizzazione e/o a ricordarne il nome.
Logo è la troncatura di logotipo che deriva dal greco λόγος - che significa “parola o discorso” e τύπος - che significa “lettera o immagine”. È una raffigurazione grafica, un design, utilizzati per rappresentare visivamente un ente, un’azienda, un prodotto, un servizio, una associazione ecc.



La progettazione di un logo spesso richiede il coinvolgimento di un team che collabora con lo studio della progettazione grafica del simbolo. In quanto opera creativa, è protetto automaticamente dal diritto d’autore, ma solo contro copie pedisseque o riproduzioni non autorizzate. Può inoltre essere tutelato tramite varie organizzazioni di proprietà intellettuale in tutto il mondo, che mettono a disposizione procedure per registrare un logo e dargli protezione legale. Il marchio registrato gode, invece, di una tutela più ampia, che permette di vietare anche usi simili per prodotti o servizi affini, oltre che identici. Nelle foto allegate, alcuni dei logo utilizzati dalla nostra Federazione nel corso dei suoi oltre 75 anni di storia ornitoculturale.
Gli esterofili amano sintetizzare il connubio logo/senso di appartenenza con il termine brand identity (letteralmente identità di marca) che in realtà è una definizione concettuale del marketing che permette di riconoscere una marca con semplicità, collegandola all’immagine del brand ed al settore di appartenenza, ovverosia l’insieme degli elementi che rendono riconoscibile un brand (nome, simbolo, logo) ed il complesso dei valori che lo contraddistinguono. Bandiere, spille e patch, che raffigurano il logo, non sono soltanto accessori decorativi ma simboli distintivi che ricoprono un ruolo straordinario e speciale, sono infatti portatori del significato dell’appartenenza e migliorano il clima







di relazione. In particolare, i distintivi e le toppe indossati o cuciti su capi di abbigliamento permettono ai membri del gruppo di portare, ovunque, un pezzo della identità associativa. Sono dichiarazioni durevoli di partecipazione e di condivisione di esperienze. L’abbigliamento è poi è uno strumento di comunicazione non verbale che esprime l’identità del gruppo. Quando i membri di uno stesso gruppo indossano gli stessi capi, si crea una visibile espressione di unità che trascende le differenze individuali, favorendo un ambiente in cui ogni membro del gruppo si sente parte di un insieme coeso. Questo senso di appartenenza è essenziale, oltre che per la motivazione individuale e collettiva, per migliorare la collaborazione e la convivenza associativa con fiducia, rispetto, collaborazione.
La F.O.I., tramite l’Ordine dei Giudici, ad ogni giudice o allievo-giudice che supera l’esame finale, oltre alla tessera, consegna il distintivo e il gilet personalizzato, con il logo dell’O.d.G., da indossare puntualmente e necessariamente in ogni manifestazione in cui si è convocati per il giudizio dei soggetti esposti. Questa forma di personalizzazione ha il potere di trasformare un apparentemente banale e semplice accessorio in un potente strumento di coesione, rammentando costantemente l’importanza della appartenenza e del contributo al successo dell’operato del collettivo.
I Giudici F.O.I. diventano pertanto parte integrante di una comunità, ciò si traduce in maggiore impegno e dedizione, contribuendo durante le fasi di
giudizio a creare una cultura di unità e di supporto reciproco (tecnico e morale). Basta poco per trasformare un gruppo di individui in una squadra coesa, motivata a raggiungere un obiettivo comune con passione e dedizione, ed a creare senso di unità e appartenenza. Inoltre questi simboli di inclusione migliorano anche l’immagine e la visibilità agli occhi del Comitato organizzatore mostra e di eventuali terzi esterni al nostro movimento ornitologico. La storia dell’uomo primitivo ci insegna che, da sempre, l’essere umano ha cercato di identificarsi come parte di qualcosa di più grande, che lo facesse sentire partecipe di un insieme più vasto. Le prime comunità di esseri umani, unite da legami di sangue o territoriali, necessitavano di una coesione forte per affrontare le sfide della natura e per difendersi dai predatori e da eventuali nemici esterni. Dalle antiche tribù che si tatuavano segni di appartenenza al medesimo clan, sino ai giorni nostri con i moderni gruppi online. Il senso di appartenenza è pertanto strettamente interconnesso e intrecciato con la nostra sopravvivenza, con la nostra storia. Il francese Émile Durkheim, sociologo, filosofo e storico delle religioni, affermava che il bisogno di appartenenza è radicato nella nostra psiche. Imprimere sul nostro corpo un marchio non è solo un modo per distinguerci, ma è anche un modo per unirci, per riconoscerci in una collettività.
In conclusione, il nostro logo continua ad essere una potente espressione di appartenenza, con la consapevolezza del suo significato più profondo e delle implicazioni culturali e sociali che comporta. Occorre tuttavia ricordare, mentre celebriamo la nostra unicità e individualità, di esaltare le connessioni che ci uniscono come gruppo di allevatori/ornicoltori F.O.I., sottolineando l’importanza di far parte della stessa comunità, della stessa Associazione, dello stesso Raggruppamento, della stessa Federazione, di avere legami e di costruire ponti, non muri o divisioni.



testo e foto di MIMMO ALFONZETTI
Abstract
Gli uccelli presentano una gamma ragguardevole di colori e motivi del piumaggio, così da dare forma a fenotipi colorati che svolgono varie funzioni, tra cui segnali di corteggiamento e comunicazione sociale, ma anche l’azione criptica per confondere i predatori. La pigmentazione della mela-
L’eumelanina nera, come è noto, è responsabile del colore del piumaggio che va dal grigio al nero

Fig. 1 -Imelanosominegliuccellihannoquattrostruttureprincipali(NationalAcademyofSciences-Maiaetal.2013): a)nanoparticelle,b)nanoverghe,c)nanoverghecave,d)piastrinecave.Lafigurabèunaprobabiledisposizioneablocchetti dei melanosomi dei canarini

nina, in questo contesto, assume un’importanza rilevante e in particolare per la cromia del nero. Nel piumaggio dei canarini il colore nero si esterna in determinate zone di convergenza (striature, marcature, etc.) conformando un disegno abbastanza tipico, ma anche nel sottopiuma (parte vaporosa), negli occhi, nelle zampe e nella ranfoteca. Le note che seguono sono una ampia digressione sulla genesi del colore nero del piumaggio; tratteranno, in una seconda parte, i meccanismi molecolari e la regolazione genica della colorazione melanica nei canarini.
Aspetti ottici
Il nero è addebitabile alla presenza di particolari pigmenti di eumelanina fortemente localizzati e agglomerati all’interno dei melanosomi. L’eumelanina nera, come è noto, è responsabile del colore del piumaggio che va dal grigio al nero, mentre la feomelanina produce un piumaggio dal giallo tenue al marrone rossastro. I melanosomi sono organelli prodotti dai melanociti, organi deputati proprio alla sintesi ed accumulo di melanina. I granelli di pigmenti sono assemblati con strutture a blocchetti (Mignone-Italia Ornitologica n. 2 -1985) e sono in grado di assorbire tutta la luce incidente. Un’indagine istologica e chimica, abbastanza recente, sulle piume di 37 razze di uccelli domestici ha altresì confermato che i melanosomi delle penne nere si presentano sotto forma di granuli conformati in maniera simile a bastoncini.
Il colore nero è l’elemento che caratterizza principalmente il disegno dei canarini della serie Neri (gialli, rossi, bianchi etc.) ma anche altri come la serie degli Agata. Sappiamo che il colore nero non è un pigmento, il nero è assenza di luce, mentre i colori ne sono un fenomeno. Il nero ha una natura strutturale ed è conseguenza dell’assorbimento totale di tutte le radiazioni luminose, proprio come se le penne avessero la proprietà di essere assorbenti. Osservate al microscopio elettronico, le penne sono estremamente frastagliate, hanno quasi una struttura frattale (figura geometrica che si ripete all’infinito uguale a sé stessa, su scala sempre più piccola). Secondo diversi autori “assomigliano a barriere coralline, spazzole o alberi con tantissime foglie”. Il risultato di questa superficie così frastagliata è che la luce, continuamente rimbalzata tra le microstrutture, è alla fine assorbita dalle penne. Si crea così un nero quasi assoluto, non ci sono om-
bre: le penne assorbono il 99,95% della luce incidente. Secondo i ricercatori, questo nero quasi assoluto non è molto diverso dal vantablack creato dall’uomo (è un materiale di carbonio 10 volte più nero di qualsiasi altro materiale) e serve a mettere in risalto le altri parti del piumaggio, che sono invece colorate e risultano in questo modo più brillanti contribuendo forse cosi alla segnalazione.
Per alcuni uccelli (merli, corvi) la livrea nera viene spiegata con l’esiguità dello strato poroso delle piume per cui le cellule midollari sottostanti contenenti eumelanina in infiniti granuli assorbono totalmente la luce incidente. È possibile estendere la medesima giustificazione al nero dei canarini anche in relazione all’organizzazione melanica in blocchetti? Ed ancora: come vengono assorbite le radiazioni, o meglio, come fanno le nanostrutture anatomiche delle penne a trattenere i fotoni e quindi l’energia luminosa ad essi associati?



Il lettore ci consentirà di azzardare un’ipotesi che, partendo da quanto asserito da Mignone (vedi I.O. 2/1985) sulle ultrastrutture dei pigmenti di eumelanina, permette di individuare un modello strutturale ottico così costituito: gruppi di melanine nere (melanosomi) organizzati in blocchetti addensati e agglomerati con minime distanze dimensionali i cui spazi possono essere colmi di pigmento melanina marrone o completamente pieni di aria. Immaginiamo, per un istante, un fascio di luce che investa i blocchetti di eumelanina e i relativi spazi infrastrutturali. Rifacendosi alla teoria corpuscolare delle radiazioni, si può pensare che i raggi incidenti e quindi i fotoni ad essi associati vengano continuamente riflessi all’interno dei blocchetti di eumelanina (fig.3), perdendo energia per urto ogni qual volta vengono a contatto con le pareti delimitanti le concentrazioni melaniche, fino alla completa disenergizzazione). L’energia cinetica persa verrà accumulata sottoforma di calore.
Il tutto sarebbe assimilabile ad una palla che, lanciata in una stanza chiusa totalmente, rimbalzi continuamente sulle pareti fino all’esaurimento dell’energia cinetica posseduta.
Al contrario, i raggi luminosi che incideranno gli spazi riempiti di melanina marrone subiranno il classico processo di diffusione, ritornando indietro con il colore selezionato dal pigmento melanico.
Resta da analizzare come le radiazioni possano penetrare senza essere riflesse negli interspazi pieni d’aria. Una parte di energia luminosa sarà dissipata all’interno dei canalicoli d’aria per effetto combinato della viscosità dell’aria e dell’adesione di questa alle pareti dei canalicoli. Con un paragone abbastanza lato, il comportamento degli interspazi vuoti di pigmento potrebbe essere assimilato a quello dei materiali fonoassorbenti che eliminano i riverberi sonori degli ambienti acusticamente protetti. Comunque, tale tipo di assorbimento copre una quota abFig. 2 -Lamorfologiadellebarbedeicanarinimelanicièsimiletratuttiitipi.Unostratoesternodicortecciacheratinica

bastanza ristretta delle radiazioni che sono maggiormente assorbite dalle strutture melaniche. Queste, in conseguenza delle loro dimensioni e della loro densità, presentano un’impedenza d’onda(le radiazioni luminose sono particolari radiazioni elettromagnetiche, onde) minore di quella dei canali pieni d’aria, per cui offriranno minore ostacolo alla propagazione luminosa. L’impedenza d’onda può semplicemente associarsi alla nozione di resistenza alla propagazione delle onde elettromagnetiche luminose.
Le spiegazioni ottiche prima enunciate trovano giustificazione anche nella composizione biochimica delle eumelanine. Le strutture melaniche hanno un’elevata densità a causa della proprietà chimica dei loro monomeri di aggregarsi in molteplici unità strutturali costituite da molecole ad alto peso molecolare. Tale densità aumenterebbe la velocità di propagazione dei fotoni all’interno di tali strutture, per cui le lunghe catene di molecole, che la polimerizzazione ha assemblato, costituirebbero delle vie preferenziali alla propagazione dei fotoni (qualcosa di simile avviene con la velocità di fuga all’interno dei buchi neri).
I cromofori del pigmento nero L’allevatore da diletto segue un iter selettivo che privilegia i canarini della serie Neri il cui disegno sia il più nero possibile (nero corvino). Il colore delle melanine è conseguenza dell’assorbimento della luce da parte dei cromofori. Questi sono raggruppamenti atomici, presenti nelle molecole di talune sostanze organiche (nel nostro caso le eumelanine), responsabili proprio dell’assorbimento di radiazioni nelle zone del visibile o dell’ultravioletto. Nelle eumelanine i cromofori sono unità (diidrossiindolo) di polimeri e nelle feomelanine anelli benzotiazinici. La visione del colore delle melanine non deriva soltanto da come queste sono legate tra loro, ma da quanti cromofori ci sono in una molecola di melanina, da quanto densamente sono impaccati e da una serie di fattori diversi (es. presenza di ioni metallici, ossidazione). Le eumelanine nere assorbono più luce delle eumelanine marroni, perché hanno più cromofori (sono più densamente impaccate a causa della ramificazione del polimero) ed è per questo che appaiono più scure. Anche le feomelanine hanno diversi cromofori che assorbono luce, però, di lunghezza d’onda leggermente diversa.


Purezza del nero
È possibile selezionare un colore nero più nero possibile (dark black)? Mah! I parametri in gioco sono tanti, vediamo di analizzarne qualcuno. Le macchie di colore melaniche negli uccelli raramente contengono puramente feomelanina o eumelanina (Mc Graw 2006). È quindi sommamente probabile che sia i feomelanosomi e sia gli eumelanosomi coesistano all’interno di una singola penna con diverse concentrazioni. Alla scansione elettronica sono distinguibili solo per la forma e non per il colore. Tuttavia, il colore della piuma corrisponde chiaramente al tipo più abbondante di melanosoma. Esiste quindi una correlazione diretta tra la forma dei melanosomi e il colore delle piume. Questa affermazione è stata appurata (McGraw, 2006) e costituisce la base delle interpretazioni del colore dei piumaggi negli uccelli. Le correlazioni eumelanosomi-forma bastoncellare e feomelanosomi-forma sub sferica sono giustificate da precedenti analisi biochimiche che hanno registrato un’abbondanza elevata di eumelanina o feomelanina nelle penne dove maggiore è la concentrazione di forme bastoncellari o forme sferiche. Appare logico dedurre che la presenza di eumelanosomi in quantità maggiore, con melanina nera e non marrone, garantisca una tonalità di nero più limpida, e quindi più satura. In generale, la melanizzazione delle penne e delle parti corneali non è un semplice processo ma si realizza in più sessioni istochimiche. I melanociti si raccolgono alla base del germe della penna posto alla radice del follicolo; adiacenti ai melanociti si trovano i cheratinociti, responsabili della sintesi della cheratina, che è la principale proteina della piuma; i melanociti posseggono numerose proiezioni dendritiche responsabili del trasferimento delle melanine ai cheratinociti delle barbe man mano che le piume si sviluppano. Occorre notare che Il meccanismo di ubicazione delle eumelanine nere e quelle marroni all’interno delle penne non è ancora perfettamente nota.



Nero più nero
Come precedentemente detto, le melanine si organizzano in granuli di forma e aspetto ultrastrutturale caratteristico (melanosomi), dispersi nel citoplasma dei melanociti, che migrano dal corpo cellulare nei prolungamenti citoplasmatici, dove vengono esocitati e trasferiti nei cheratinociti dello strato basale. In maniera molto elementare, questo processo può essere suddiviso in due fasi distinte:
• formazione di melanina in seno ai melanociti
• passaggio dei melanociti ai cheratinociti circostanti
Pertanto, l’intensità del pigmento visibile nelle piume non è determinata solamente dall’attività pigmentaria dei melanociti, ma anche dalla modalità, dalla velocità di trasferimento e dal modo di distribuzione dei melanosomi ai cheratinociti.
La formazione di melanina in seno ai melanociti è regolata da numerosi fattori dipendenti da:
• chimica
• dimensioni
• concentrazioni
La chimica istologica ci suggerisce che le eumelanine si formano attraverso un processo di ossidazione della tirosina sotto l’influenza della tirosinasi, un enzima contenente rame. Dorris (1938) ha indicato che l’intensità del colore delle eumelanine dipende
dallo stadio in cui termina l’ossidazione della tirosina, poiché si è osservato che i melanosomi appaiono prima come piccoli granuli gialli, per poi diventare più grandi e contemporaneamente marrone scuro o nero. Quindi, le differenze nello stato di ossidazione della stessa sostanza portano allo sviluppo di diverse tonalità della melanina. Se l’ossidazione sarà spinta al massimo le melanine saranno nere, altrimenti un melange (di nero, marrone scuro, marrone) sarà la risultanza della cromia nera finale. Le dimensioni dei melanosomi hanno importanza sul colore nero finale. Gli eumelanosomi hanno forma bastoncellare, sono tipicamente allungati (800-1000 nm di lunghezza, 200-400 nm di larghezza) e con estremità arrotondate, mentre i feomelanosomi sono ovoidali e subsferici e variano in misura maggiore; la maggior parte ha una lunghezza compresa tra 500 e 700 nm e 300 e 600 nm di larghezza [Nota, 1 nm o nanometro, è un milionesimo di millimetro].
I melanosomi dimensionalmente più grandi mostrano radiazione nera più intensa, ma queste dimensioni devono rientrare in un range praticabile perché sembra che i macromelanosomi abbiano difficoltà a trasferirsi nelle penne, conseguendo quindi un risultato contrario. È quello che succede nei canarini Opale. (M. Alfonzetti, I.O. n° 3 e 4-2024)
Le concentrazioni dei melanosomi (meglio, la densità per unità di superficie citoplasmatica) sono ampiamente correlate con il colore nero, nel senso che maggiore è la densità per unità di superficie maggiore sarà il tono del nero.
È importante che i melanosomi si disperdano nel citoplasma dei melanociti, occupando quanto più superficie possibile e non agglomerarsi in gruppi isolati. Dovranno ridurre al minimo gli spazi vuoti, evitando così la riflessione luminosa degli spazi non coperti. Al contrario, se i melanosomi si concentrano, il tenore del nero diminuisce e la colorazione può virare verso il grigio, in particolare se la riflessione da parte degli spazi della superficie citoplasmatica non pigmentata diventa consistente.
Il passaggio dei melanociti ai cheratinociti circostanti e il trasferimento delle melanine alle piume condizionano ulteriormente la saturazione del nero. Man mano che si formano le barbe e le barbule di una piuma, i melanociti (Gordon, 1953) trasferiscono il loro pigmento alle cellule di cheratina delle piume. Gli elementi che influenzano il tenore del nero nelle penne sono:
• ubicazione delle melanine
• struttura del piumaggio
• ultrastruttura della barba
• presenza dei lipocromi

L’ubicazione delle melanine nere e di quelle marroni all’interno delle strutture della barba, in particolare il meccanismo della collocazione, non è ancora perfettamente nota. La diversa posizione dei melanosomi modula in maniera significativa l’energia di assorbimento e l’intensità del nero. Le melanine si depositano nelle cellule cheratiniche della parte esterna della corteccia (più o meno superficialmente) o nella parte interna adiacente alla zona midollare. La contemporanea presenza di melanine nella corteccia e nella zona midollare rinforza la saturazione del nero; questa subirà una evidente riduzione se le melanine sono maggiormente localizzate solo nella zona midollare o solo nella zona corticale. È opportuno ricordare, nei canarini della serie Opale, che le melanine corticali si addensano nella porzione inferiore della barba.
La struttura del piumaggio contribuisce
all’intensità del colore nero. Uno studio relativamente recente (Galvan 2011), che però non ha esplorato gli uccelli domestici, ha evidenziato che le penne nere a base di melanina con barbule e barbe più folte risultavano di un colore più scuro; a mio parere, questa affermazione può ritenersi appropriata anche per i canarini. Un numero maggiore di barbule nei canarini può consentire alle barbe di bloccarsi più strettamente, creando potenzialmente una superficie più liscia e continua; tale superficie offrirebbe una zona che potrebbe essere causa di maggiore assorbimento.
L’ultrastruttura della barba può desumersi dalla sezione (fig.2) della barba generica di canarino. Uno strato esterno di corteccia cheratinica circonda la zona spugnosa, che al suo interno racchiude successioni di melanosomi. Una presumibile restrizione della zona spugnosa, circostanza verificata anche sugli psittacidi, costituisce un fat-
tore di scurimento della visione cromatica nera e avvicinerebbe la superficie di assorbimento, realizzata dai melanosomi aggregati, al diretto irraggiamento; il cammino ottico è più breve e l’assorbimento verrebbe limitato soltanto dalla corteccia.
Interferenze sulla purezza del nero
La presenza di lipocromi influenza il colore nero. Nella corteccia delle barbe si diffondono, oltre alle melanine, anche i lipocromi. Quest’ultimi assorbono una frazione dell’energia luminosa destinata alle melanine e la relativa riflessione colorata inquina la qualità cromatica del nero. I canarini apigmentati dovrebbero essere sfavoriti nell’espressione del nero causa la massiva riflessione del bianco delle penne, nonostante il contrasto dei colori del piumaggio più evidente.





Può esistere, comunque, una densità soglia di melanina oltre la quale lievi variazioni non fanno alcuna differenza per il colore. In altre parole, la melanina può saturarsi nella piuma e l’aggiunta o la sottrazione di alcuni melanosomi non influisce più sul colore. Non c’è quindi certezza che tutti i melanosomi prodotti all’interno dei melanociti confluiscano all’interno delle piume per colorarle di nero. Un po’ tutti i ricercatori mostrano cautela quando attribuiscono le variazioni nel colore a base di melanina alla sola melanina, ma viene presa in seria considerazione anche la microstruttura della penna e piuma. Sembra che nelle barbe che propagano radiazioni bluastre i melanosomi siano
localizzati alla base interna dello strato spugnoso, ma non sono presenti nella corteccia esterna o nello strato spugnoso. Il posizionamento della melanina nella corteccia sembra mascherare l’espressione del blu strutturale. Anche la temperatura ambientale interferisce sulla sintesi della melanina. La temperatura modula in modo significativo la melanogenesi, agendo soprattutto sull’attività degli enzimi chiave e sul disegno adattativo del piumaggio. La tirosinasi, enzima principale nella conversione della tirosina in melanina, presenta un profilo ottimale di funzione in un certo intervallo termico. Enzimi chiave proprio come la tirosinasi hanno un’attività ottimale a tempera-


ture moderate; durante la crescita del piumaggio in ambienti relativamente freddi, la produzione di melanosomi e la concentrazione di eumelanina aumentano.

Un discorso a parte, ma non meno importante, è la lucentezza del nero, che invece interferisce positivamente sulla sua espressione. Le immagini di figura 4 (immagini TEM) ci vengono in aiuto e ci permettono di comprendere, in termini di morfologia, la differenza tra un nero opaco e un nero lucido. La figura 4(d) mostra la sezione di una barbula di un piumaggio nero opaco (Quaglia californiana) mentre la figura 4(e) la barbula di un piumaggio lucido (Corvo comune). La microscopia elettronica a trasmissione ricostruisce l’immagine (e) sognata da ogni allevatore di canarini: il “nero corvino” La lucentezza è strettamente legata alla dimensione dei melanosomi e alla loro disposizione all’interno delle barbule. Appare evidente in figura (e) la dimensione dei melanosomi decisamente più grande nel corvo comune e il loro addensamento nella parte distale della barbula, la parte più esterna (la punta).
A margine, ma non perché meno importante, la figura 6 (immagini TEM) mostra la morfologia di barbule di un Gracchio dalla coda a barca (Quiscalus major). È un uccello passeriforme della famiglia degli Icteridae, residente permanente sulle coste degli Stati Uniti mediorientali e medio-atlantici. I maschi adulti hanno un piumaggio completamente nero, lucido con diffusioni bluastre e iridescenti, un lungo becco scuro. I granuli di melanina, di riconoscibile grande dimensione, pur manifestando continuità si aggregano concentrandosi nella periferia della barbola, ai bordi estremi motivando così la iridescenza. Chissà se questa nano-organizzazione morfologica possa essere adottata anche per l’azzurro dei nostri canarini Opale.
Fonti
-Open Laboratory 2007, The Best Science Blog Writing of 2007.
-Rafael Maia, Liliana D’Alba, Matthew D. Shawkey (2011). What makes a feather shine? A nanostructural basis for glossy black colors in feathers, Proceedings of the Royal Society B, 278, 1973–1980
-M. Alfonzetti, Italia Ornitologica 3 e 4-2024

testo di SIMONE OLGIATI, FOTODI S. OLGIATI eA. MANZOLI
Reggio Emilia, 1° giugno 2025
A fine primavera, quando il clima si è già fatto estivo, viene organizzata a Reggio Emilia l’esposizione “ColoradoLoverbird”, specialistica dedicata ai Pappagallini ondulati e ai membri del genere Agapornis, a cui si aggiunge una partecipata mostra scambio. Era quest’ultima ad interessarmi maggior-
mente, per cercare lì qualche nuovo soggetto da aggiungere all’allevamento e cedere quelli che non rientravano più nei programmi di riproduzione.
Nel mio girare tra i tavoli incontrai e salutai tantissimi amici, coi quali discussi della stagione appena trascorsa, dei risultati raggiunti e dei progetti per




Ibrido appena nato. Se la morfologia generale ricorda i pulli di Passero del Giappone, le macule ai lati del becco sono certamente ereditati dal Diamante quadricolore, foto: AngeloManzoli
le cove autunnali. Tra loro c’era anche Alessandro Cinti, eccellente allevatore e ibridatore di Lonchure, Erythrure e Diamanti mandarini, al quale raccontai degli Ibridi da me realizzati in questa stagione cove, per fortuna numerosi e di buona qualità.
Parlando di ibridi, Alessandro mi riferì di aver sentito che una conoscenza in comune aveva ottenuto, in maniera puramente casuale, un incrocio rarissimo, mai visto prima. Ovviamente ciò stuzzicò molto il mio interesse; tuttavia, data la portata della notizia rimasi un




po’ scettico. Nel corso della discussione chiesi delle foto per confermare quanto Alessandro mi stava dicendo e mi venne fatto vedere un video del soggetto in questione, ancora in piumaggio da nido. In effetti, erano visibili entrambi i parentali dichiarati, sia nella forma che nel colore, ma non rimasi ancora del tutto convinto. Chiesi ad Alessandro chi fosse l’allevatore che aveva ottenuto il soggetto e lui rispose: “È lì due tavoli avanti, me l’ha mandato lui il video. Dovrebbe avere anche qualche foto. Prova a chiedergliele, magari te le fa vedere!”. Così mi diressi dalla persona indicata, che scoprii essere l’amico Angelo Manzoli, anch’egli eccellente allevatore di esotici, australiani e melanesiani. Discutendo con lui riuscii a carpire numerose informazioni su come questo ibrido fosse nato e mi feci raccontare tutta la sua storia. Angelo mi mostrò una foto dell’incrocio appena nato, al primo giorno di vita. Da quello scatto potei constatare che l’ibrido tanto chiacchierato era effettivamente figlio dei parentali dichiarati, grazie al bordo del becco ben visibile. L’ibrido era inequivocabilmente figlio di un Diamante quadricolore e di un
L’ibrido era inequivocabilmente figlio di un Diamante quadricolore e di un Passero del Giappone
Passero del Giappone. Conclusa la conversazione, Angelo ed io rimanemmo d’accordo di incontrarci per fare delle foto all’incrocio in una apposita gabbia fotografica, appuntamento che avvenne in settembre.
Grattacoppa, 19 settembre 2025 Per il servizio fotografico venne scelto il giorno 19 di settembre ’25, in concomitanza con il weekend della manifestazione “Zebra’s” dedicata al Diamante mandarino e agli esotici d’allevamento. Caricata la macchina con tutto il necessario, partii da casa alle 8 del mattino e arrivai a destinazione alle 11, dove Angelo mi accolse con un gran sorriso. Sistemata la gabbia fotografica su un tavolino passammo diversi mi-
nuti a chiacchierare dell’allevamento, delle specie alloggiate, delle tecniche adottate per favorirne la riproduzione e osservai con attenzione le numerose gabbie che riempivano le pareti della stanza. Dopo un po’ l’occhio cadde su una gabbia da esposizione tenuta in penombra dove, di primo acchito, non capii che specie vi fosse alloggiata. “Si tratta dell’ibrido, è lì dallo svezzamento!” esclamò Angelo che, giustamente, attese del tempo prima di farmi vedere l’oggetto del desiderio. Presi il soggetto in mano e mi godetti per qualche istante la sua visione, con la mano e la voce tremanti. Posizionato l’uccellino nella gabbia fotografica e dopo aver aspettato che salisse sul posatoio mi dedicai a fare gli scatti. In un primo momento l’ibrido era abbastanza agitato e svolazzava nella gabbia ma quando si calmò e si posò nel punto giusto mise in risalto la sua forma elegante e i colori brillanti del piumaggio. Realizzato un numero sufficiente di fotografie e di video, l’ibrido venne riposto nel suo alloggio abituale per continuare la preparazione per le esposizioni. Le chiacchiere continuarono fino all’ora di pranzo, quando mi congedai e salutai calorosamente Angelo, soddisfatto anche lui della mattinata appena trascorsa.
La storia dell’ibridazione
Nel corso dei due incontri Angelo mi raccontò la genesi dell’ibrido e gli antefatti che lo riguardavano. Tutto era iniziato con un maschio di Diamante quadricolore del 2022 che generò, in purezza, circa due dozzine di piccoli nel giro di due anni. Purtroppo, nel 2024 cominciò a manifestare dei problemi neurologici con perdita d’equilibrio e mancanza di coordinazione e ciò portò Angelo a isolare il soggetto e a trattarlo con una cura fornita da un veterinario aviario. L’uccellino rispose bene alle cure e si riprese completamente ma venne comunque tenuto lontano dai conspecifici e venne posto in un gabbione da 90 centimetri in compagnia di due femmine di Passero del Giappone pezzate. Alla gabbia erano rimasti appesi due nidi utilizzati dalle femmine per passarci la notte.

Dopo qualche tempo, il maschio cominciò a corteggiare con insistenza entrambe le compagne, le quali allestirono i rispettivi nidi e lì iniziarono a deporre. Le prime uova vennero deposte nei due nidi, successivamente entrambe le femmine deposero in una sola cassettina, per un totale di cinque uova. Passati i canonici quattro giorni di cova assidua, Angelo fece la speratura delle uova e con incredibile sorpresa scoprì che uno di questi era fecondo. Posto quest’uovo sotto una coppia di Passeri del Giappone, l’uovo si schiuse ma l’ibrido morì nel giro di ventiquattr’ore.
Ci fu una seconda covata, anche questa con un uovo fecondo, sempre affidato alle balie, ma dopo sedici giorni di incubazione non si era ancora schiuso. Angelo allora lo prese e provò ad aprirlo per salvare il piccolo in esso
La forma e la struttura ricordano molto di più il Diamante quadricolore che il Passero del Giappone
contenuto. Malauguratamente l’ibrido aveva bisogno di un giorno in più d’incubazione; dopo poco tempo fece la fine del fratellino.
La terza deposizione fu una fotocopia delle precedenti, cioè numerose uova deposte, di cui uno solo fecondo. Fortunatamente quella volta l’uovo si schiuse e l’incrocio venne svezzato senza troppi problemi grazie alla robustezza data dal vigore ibrido e dalla ricca alimentazione fornita ai genitori putativi. Purtroppo, a due mesi di vita cominciò a manifestare le stesse problematiche neurologiche del padre, le quali vennero fortunatamente risolte con il medesimo trattamento farmacologico fornito al genitore. La muta proseguì senza intoppi e si completò serenamente all’interno della stessa gabbia dove l’ho visto alloggiato, dove viene coccolato e curato amorevolmente.
Analisi del fenotipo dell’ibrido
Ad un primo impatto, soprattutto in condizioni di luce non ottimale che non fanno apprezzare appieno i colori, l’ibrido assomiglia ad un incrocio di Passero del Giappone x Padda. Il portamento fiero, impettito, la taglia importante, la coda larga e lanceolata sono elementi in comune tra queste due tipologie di ibridi. In generale la forma e la struttura ricordano molto di più il Diamante quadricolore che il Passero del Giappone, così come il comportamento e l’atteggiamento, schivo e scattante. Curiosamente, il canto e la posizione assunta mentre questo viene emesso sono del tutto similari a quelli del Passero del Giappone.
I colori dell’ibrido sono sicuramente l’elemento più sconvolgente e interessante dopo la realizzazione stessa dell’ibridazione in oggetto. Se viene visto in condizioni di luce scarse, l’ibrido ha un tono generale brunastro, più scuro sulle parti superiori e più chiaro in quelle inferiori. Appena il soggetto viene posto alla luce, esso rivela delle sfumature che, se non ci fossero le fotografie dell’animale, sarebbero inimmaginabili. La coda è verde giallastro brillante, quasi dorata, mentre il codione è più scuro. Il dorso è anch’esso verde ma di tonalità fredda, tra il verde smeraldo e il verde foglia. La testa è grigiastra ed è presente una sottile maschera nera che contorna il becco. Il petto ha un colore simile a quello della coda ma è più evidente il tono dorato. È presente una leggera barratura nera che divide il petto dal ventre e quest’ultimo presenta un leggero disegno a lisca di pesce su uno sfondo beige. Le remiganti sono praticamente nere, come la pagina inferiore delle timoniere. Il sottocoda presenta un disegno simile a quello ventrale. Sfortunatamente, come si vede dalle fotografie allegate, l’ibrido presenta delle evidenti pezzature sulle ali, ventre e testa che lo rendono competitivamente poco valido. Questo dettaglio non può e non deve sminuirne l’importanza tecnico-scientifica. Anzi, per via della loro natura aleatoria, le pezzature rendono ancora più unico questo incrocio di quanto non lo sia già.





Considerazioni e riflessioni sulla filogenesi e sistematica degli Estrildidi
Il Diamante quadricolore e il Passero del Giappone sono certamente due specie molto distanti, sia dal punto di vista filogenetico che come aspetto esteriore. Come si può vedere dagli studi effettuati da Urban Olsson e Per Alström pubblicati nel 2020 (Olsson, Urban; Alström, Per (2020). “A comprehensive phylogeny and taxonomic evaluation of the waxbills (Aves: Estrildidae)”. Molecular Phylogenetics and Evolution. 146 106757. Bibcode:2020MolPE.14606757O. doi:10.1016/j.ympev.2020.106757. PMID 32028027. S2CID 211048731.), l’ultimo antenato in comune a tutti gli Estrildidi risale ad un momento compreso tra 12,3 e 9,5 milioni di anni fa ed è proprio questo progenitore “universale” ad essere l’avo che il Diamante quadricolore e il Passero del Giappone condividono. Le reali affinità tra gli Erythrurini e gli altri Estrildidi sono ancora poco chiare, ma c’è una possibilità debolmente supportata che abbiano maggiori affinità con la sottofamiglia Amandavinae. In ogni caso, gli Erythrurini sono un insieme di specie antico, ben differenziato dagli altri Estrildidi e abbastanza omogeneo al suo interno. Se di ibridi tra i membri del genere Erythrura se ne sono visti molti, come Diamante di Kittlitz x Diamante di Tanimbar e x Diamante pappagallo, di incroci con altri generi, fino ad oggi, non abbiamo avuto testimonianza fotografica. Esperienze aneddotiche raccolte negli anni affermano di uova feconde di Diamante di Tanimbar x Diamante codarossa e di adulti di Diamante di Kittlitz e di Diamante pappagallo x Diamante codarossa. Si è avuta notizia di un uovo fecondo, il cui sviluppo embrionale si è interrotto attorno all’ottavo-nono giorno di incubazione, prodotto dall’accoppiamento tra Astro di Reichenow e Diamante di Kittlitz. Finalmente, grazie alle fotografie allegate di Diamante quadricolore x Passero del Giappone, abbiamo la “pistola fumante” che è possibile incrociare gli Erythru-
rini con gli altri Estrildidi, anche con quelli che, di primo acchito, possono sembrare troppo diversi e poco affini etologicamente e filogeneticamente.
Conclusioni
Il fatto che il Diamante quadricolore e il Passero del Giappone abbiano avuto prole è una notizia di grande portata sia da un punto di vista prettamente ornitofilo sia per ciò che riguarda la sistematica e l’ornitologia in generale.
È possibile pensare che gli Estrildidi siano un gruppo geneticamente più “affine” di quanto il mondo ornicolturale sia abituato a pensare. Le ibridazioni tra Estrildidi africani con il già citato Passero del Giappone e col Diamante mandarino supportano questa ipotesi, poiché anche questi incroci sono avve-
Il fatto
che il Diamante quadricolore e il Passero del
abbiano avuto prole è una notizia di grande portata
nuti tra specie che condividono come progenitore collettivo l’ultimo antenato comune a tutti gli Estrildidi. Sono quindi certamente immaginabili ibridazioni tra tutti i membri di questa famiglia, nessuno escluso. Alcuni di questi potrebbero essere accattivanti da un punto di vista spiccatamente fenotipico e sportivo: sarebbe veramente da sogno Diamante quadricolore x Astrilde testa azzurra… ma questa è un’altra storia.
Ringraziamenti
Ringrazio gli amici: Alessandro Cinti per la “soffiata” datami in quel di Reggio Emilia, Angelo Manzoli per aver prestato il soggetto alle fotografie allegate e Valerio Manenti per l’editing degli scatti.




Il mondo ornitologico mi ha dato l’occasione, nel corso degli anni, di conoscere un numero importante di appassionati; con alcuni di loro si è instaurato un rapporto unico, che mi ha permesso di trascorrere diversi decenni in buona compagnia, confrontandoci e condividendo questa splendida passione; tutto ciò ha consentito di allargare i miei orizzonti e di scoprire l’affascinante mondo degli Psittacidi.
Con due di loro, Pierluigi Cacciola e Claudio Garbarino, grandissimi appassionati di pappagalli ed ottimi allevatori, si è formato un ottimo trio, cosa che ci ha fatto ammirare, nel tempo,

le mostre più importanti in giro per la penisola, o di trovarci spesso, la domenica mattina, in viaggio verso Fossano al mercatino organizzato dagli
L’amico
Renzo Esuperanzi mi ha fatto conoscere Giacinto, un grandissimo appassionato di pappagalli
appassionati amici cuneesi. Dopo il mio trasferimento in Puglia, una decina di anni fa, queste “scorribande” si sono interrotte, anche se l’amicizia è rimasta tale, e di conseguenza mi sono allontanato dal mondo “Psittacus” fino a quando l’amico Renzo Esuperanzi mi ha fatto conoscere Giacinto, un grandissimo appassionato di pappagalli, più precisamente del Parrocchetto dal Collare (Psittacula krameri) e delle sue mutazioni. La sua passione mi ha portato a scrivere questo breve articolo per rendergli onore e ringraziarlo per gli splendidi esemplari che riesce a realizzare ogni anno.




Il Parrocchetto dal collare in natura Psittacula krameri è un pappagallo della famiglia degli Psittacidi che deve il proprio nome alla presenza di una particolare banda nera che gli circonda il collo. È tra le specie più diffuse al mondo e il suo allevamento non richiede particolari documentazioni Cites.

Deve il proprio nome alla presenza di una particolare banda nera che gli circonda il collo

La colorazione ancestrale è verde lime, ad eccezione del blu turchese presente nella coda e degli anelli neri e rosa intorno al collo dei maschi, che si evidenziano entro il terzo anno d’età. Quando questi pappagalli sono in volo, le penne delle ali e della coda mettono in mostra un giallo brillante che è visibile solo dal basso. Il becco è color rosso ciliegia.
Il dimorfismo sessuale è evidente perché le femmine sono sprovviste del colletto rosato; hanno le penne della coda più corte e, inoltre, presentano una colorazione meno bluastra sul collo. Gli individui giovani hanno il becco leggermente più chiaro ed assomigliano alle femmine. Esistono quattro sottospecie di “collari”: krameri, parvirostris, borealis e manillensis, con caratteristiche morfologiche leggermente differenti. Raggiunge i 45 centimetri circa di lunghezza e può arrivare a 140 grammi di peso.
Questa specie di parrocchetto è considerata piuttosto longeva; infatti, sebbene non sia chiaro quanto possa vivere in natura, secondo quanto riportato dal Museo di Zoologia dell’Università del Michigan, in passato un soggetto ha vissuto in ambiente

controllato fino a 34 anni.
È originario del subcontinente indiano e dell’Africa centro – settentrionale; è presente, infatti, nella zona che va dalla Guinea alla Mauritania, nell’area occidentale e dall’Uganda al Sudan a est.
In Asia lo possiamo incontrare dal Pakistan occidentale all’Afghanistan, all’India, al Nepal, in Myanmar e a Ceylon.
L’uomo lo ha introdotto – volontariamente e non – in Egitto, nella Penisola Arabica, in Europa, in Nord America, dai Caraibi al Giappone e alle isole Hawaii.
È considerato nocivo per i raccolti, soprattutto per quelli di cereali, caffè e per gli orti. La stagione riproduttiva va da agosto a novembre per le popolazioni africane, da dicembre a maggio per quelle indiane e da novembre a giugno per la popolazione di Ceylon. Per quanto riguarda le popolazioni italiane, nidifica da maggio ad agosto.
È considerata una delle peggiori cento specie invasive presenti in Europa. Nelle aree di provenienza provoca molti danni alle colture agricole; in Italia, per ora, ha una localizzazione sostanzialmente urbana, ma non è detto che in futuro, vista la sua elevata invasività, non possa produrre

Il dimorfismo sessuale è evidente perché le femmine sono sprovviste del colletto rosato

danni all’agricoltura. Per le sue abitudini riproduttive, è un competitore di altre specie di uccelli indigene nidificanti in cavità come Torcicollo, Picchio muratore, Picchio rosso maggiore.
Le popolazioni presenti in Italia hanno avuto origine da individui fuggiti dalla cattività, anche se non è da escludere il rilascio intenzionale. Le prime osservazioni di individui in libertà risalgono agli anni ‘70 del secolo scorso. A Roma, la prima nidificazione di “collare” accertata risale al 2002 ed è attualmente molto diffuso.
Vi sono numerose popolazioni stabili da nord a sud: sono stati segnalati nel centro di Genova, nel Parco di Monza, nella città di Bolzano, nell’Orto botanico di Palermo in Sicilia, in generale in tutta la provincia di Pavia (anche in città nella zona del Castello Visconteo), a Ferrara; avvistamenti si sono avuti anche a Milano al Parco Forlanini, al Parco Ravizza, al Parco Nord, al Parco Sempione, al Parco Lambro, al Parco delle Cave, all’Idroscalo; inoltre, in provincia di Milano, a Paullo, soprattutto nei parchi cittadini; presenze pure in Toscana (soprattutto al parco delle Cascine a Firenze) ed in provincia di Bologna e in Puglia. Avvistamenti anche nel





Nel suo ambiente naturale vive nelle savane alberate, nelle boscaglie, nelle foreste secondarie
parco della Reggia di Caserta e financo a Salerno ed a Napoli. Nel suo ambiente naturale vive nelle savane alberate, nelle boscaglie, nelle foreste secondarie e non è raro incontrarlo nei giardini e nei campi coltivati. È stanziale, ma nelle zone agricole avvengono movimenti locali a seconda delle stagioni dei raccolti.



Allevamento in ambiente controllato
La sua grande adattabilità all’ambiente captivo, la sua rusticità e soprattutto le sue numerose mutazioni lo hanno reso uno dei pappagalli più allevati al mondo.
Giacinto Giannandrea, oltre ad essere uno dei migliori salumai delle Marche –e non solo –, allevatore di vecchia data, è riuscito nel tempo a selezionare un ceppo veramente rustico, con soggetti che hanno mantenuto un’ottima struttura e taglia e dei colori splendidi.
Andiamo ora a scoprire alcuni dei suoi segreti alla base di questo successo. L’allevamento è composto da diverse voliere ben sistemate, immerse nel verde all’ombra di numerosi alberi, il tutto a ridosso della sua residenza;

egli fornisce alle coppie presenti nel suo aviario una miscela di semi così composta:
50% scagliola
30% miglio bianco
12-14% girasole striato
3% canapa
3% cardo bianco
Arachidi sgusciate
Questa miscela è frutto di esperienze personali ed è stata affinata nel tempo.
Oltre a questo misto “secco”, nei vari periodi dell’anno completa la dieta con la cicoria, al di fuori del periodo riproduttivo, cocomero, cetriolo, finocchio e carota.
Vista la salute dei soggetti, si può sicuramente affermare che non serva null’altro al collare per essere in splendida forma.
Questo intraprendente allevatore ha realizzato uno speciale soffiasemi (di cui allego foto) per poter

recuperare parte della miscela non consumata.
Diverse sono le mutazioni presenti attualmente in allevamento, tra cui comuni (gialli e verdi) e cleartail, con colori splendidi e stacchi netti tra le varie tonalità, come si può ammirare dalle foto allegate. Giacinto mi ha spiegato l’importanza dei portatori, il vero “segreto” del suo allevamento: utilizzandoli, si otterrà sicuramente un numero minore di soggetti mutati, ma si manterrà un’ottima struttura nei piccoli nati.
La stagione riproduttiva, nelle Marche, va da marzo a giugno, prima dell’arrivo del grande caldo. Con queste poche regole il buon Giacinto ogni anno realizza splendidi soggetti apprezzati da tutti gli appassionati e sempre vincenti nelle varie mostre a cui decide di partecipare.














testo di GIOVANNI CANALI, foto S. GIANNETTi e P. ROCHER
Ho partecipato a discussioni sulla faccenda dei pezzati nei canarini di forma e posizione, sia lisci che arricciati, nonché in generale. Tenendo sempre presenti le regole vigenti in queste razze.
So che ci sono indicazioni da parte internazionale e che non tutti hanno le stesse posizioni. Mi premuro di essere distaccato, nei limiti del possibile, affrontando questo tema, ed anche rinverdendo i ricordi di quando avevo canarini di forma e posizione, specialmente arricciati. Del resto a Parma decenni or sono era quasi indispensabile passare dall’Arricciato del sud e magari dal Gibber italicus. Ho sempre ritenuto che, prima di pensare alle pezzature, nelle razze di forma e posizione sia necessario distinguere l’intenso dalbrinato, sia nell’accoppiamento che nel giudizio. Pertanto, prima di parlare di pezzati ritengo necessario riferirmi alla categoria, molto più importante. Non sempre gli allevatori delle razze suddette hanno le idee chiare. Molti anni or sono, quando parlavo di intensi e brinati mi contrapponevano il fatto che nelle razze di forma e posizione valgono le forme e la posizione, non il colore, concetto ovvio, ma da chiarire. Allora dovevo pazientemente spiegare che non era tanto un fatto di colore ma di struttura del piumaggio e delle altre produzioni cutanee. In effetti, data l’interferenza dell’intenso sul piumaggio e di conseguenza sulla forma, cambia qual-

Ci sono indicazioni da parte internazionale e non tutti hanno le stesse posizioni


cosa e non da poco. Citavo l’espressione, anche se non precisa del passato, quando nel Parigino si parlava di piumaggio: duro, semi duro e morbido, ove per duro e semi duro si alludeva all’intenso e con morbido al brinato, indicando la necessità dell’incrocio. Talora si parlava anche di dorato e pagliato, ove per dorato si intendeva intenso (ora il significato è diverso) e per pagliato brinato, sempre da incrociare. Nelle diverse razze l’espressione morfologica cambia a volte in misura rilevante. Il guaio è che nelle razze ove è favorito l’intenso si tende ad accoppiare intenso x intenso e dove è avvantaggiato il brinato, brinato x brinato. Con le conseguenze note. Nel Gibber italicus abbiamo oggi solo doppi intensi; per ricordare qualche brinato o singolo fattore intenso, devo risalire con la memoria a diversi decenni or sono. Nell’Arricciato del nord sono quasi tutti brinati. Nel Gloster gli intensi erano pochi, oggi qualcuno in più; si era arrivati, a furia di accoppiare fra brinati, ad avere soggetti così slavati da essere biancastri. Ci fu perfino qualcuno che pensò di usarli per fare il “nuovo mosaico”, con la conseguenza di trasmettere al Canarino di colore lumps e depigmentazioni... Ho già fatto abbastanza commenti. Ribadisco però che soltanto un accoppiamento misto ogni 3 o 4 generazioni, come si diceva, non basta a mantenere l’equilibrio. Ritengo utilissimo per non dire indispensabile prevedere categorie a




concorso diverse per intensi e brinati. Gli apigmentati lipocromici, cioè i bianchi, venivano di solito fatti gareggiare con i brinati. Quando c’è una razza ove è avvantaggiato il brinato non succede nulla di molto grave, semplicemente i bianchi intensi ben difficilmente possono piazzarsi. Quando però sono avvantaggiati gli intensi è un guaio, poiché un ottimo bianco intenso gareggiando con i brinati li schiaccia. Mi è stato raccontato l’episodio di un Fife, mi pare, nero bianco intenso ottimo, che imperversava, battendo facilmente i brinati con i quali gareggiava. Di conseguenza dico che sarebbe molto meglio che gli apigmentati lipocromici (i bianchi), gareggiassero a parte, come avviene spesso atualmente. Un problema che si presentava, ma oggi molto meno, è dato dalla difficoltà di distinguere gli intensi dai brinati, segnatamente nelle razze a piumaggio molto abbondante. Ricordo che una volta venni interpellato per un dubbio su di uno York pezzato giallo intenso. Il dubbio nasceva dalle depigmentazioni a forma di orlature che apparivano sulle parti melaniche simili a brinature. Feci notare che le depigmentazioni erano solo sulle parti melaniche e che nessuna brinatura era presente
Le brinature vere attengono ai lipocromi e non possono essere visibili in soggetti bianchi e pure melanici a fondo bianco
su quelle ipocromiche, facendo anche confronti con veri brinati. A proposito di depigmentazioni che attengono alle melanine e che a forma di orlatura possono generare dubbio, si sappia che le brinature vere attengono ai lipocromi e che non possono essere visibili in soggetti bianchi e pure melanici a fondo bianco. Purtroppo ricordo con rabbia un episodio che riguardava un tecnico del colore molto seguito che, con arroganza, pretendeva di vedere brinature in melanici a fondo bianco! Ne venne fuori una discussione alquanto sgradevole, sarebbe stata una roba degna di sanzioni corporali. Un altro episodio di dubbio, nel quale venni interpellato, riguardava un soggetto di razza spagnola giallo avorio intenso. Il dubbio riguardava la tonalità troppo
chiara del lipocromo per un giallo intenso. Si trattava di uno dei primi avorio in quella razza, effettivamente intenso, come spiegai, anche con un confronto con avorio canarini di colore. Concludendo il tema della categoria, preciso che il mosaico eventuale va sicuramente assimilato al brinato, poiché la sua struttura è quella; il mosaico intenso come alcuni dicono, non esiste, è solo più contenuto rispetto a quelli in eccesso.
Ora finalmente considero i pezzati ed i macchiati. In questo scritto, il termine pezzato lo uso solo per i veri pezzati; i lipocromici con macchiette o i melaninici con timoniere e/o remiganti lipocromiche o poco altro li chiamo macchiati per distinguere. La differenza genetica è molto seria; infatti, accoppiando due veri pezzati si ha il 25% di lipocromici, il 50% di pezzati ed il 25% di melanici, poco importa che i lipocromici (tutti) ed i melanici (alcuni) siano macchiati. Mentre accoppiando due macchiati lipocromici si ha il 100% di lipocromici, ancorché tutti macchiati o quasi, e accoppiando due melanici macchiati si ha il 100% di melanici, alcuni macchiati ed altri no. Si nota quindi una notevole prevalenza dell’espressione melanica.

Ricordo che accoppiando un melanico con un lipocromico si ha il 100% di pezzati, almeno nel canarino, poiché se si accoppiasse il canarino lipocromico con altre specie, ovviamente melaniche, gli ibridi pezzati sarebbero pochi. In letteratura antica si dava l’acianismo, responsabile dell’inibizione delle melanine, generando gli acianici, detti anche lipocromici, come geneticamente a dominanza parziale ed espressività variabile. Una dizione poco lontana dall’esattezza, tuttavia ho precisato che la penetranza è completa nei canarini puri, ma diventa molto ridotta negli ibridi (ci sono molti melanici e pochi pezzati o macchiati) e che non ritengo si possa parlare di un solo gene, anche se certamente ve ne è uno nettamente predominante. Quest’ultimo aspetto deriva dal fatto che le macchie nei lipocromici si possono tranquillamente giustificare con l’espressività variabile, ma non le piccole parti acianiche nei melanici. Le tracce acianiche (lipocromiche) si trovano con diverse frequenze anche in ceppi di melanici lontanissimi dagli antenati acianici, ove si accoppia sempre melanico pulito x melanico pulito. Que-
sto fa pensare a qualche gene ulteriore, del tutto secondario e subdolo nella trasmissione, che appare davvero insolita. Per completare il discorso dovrei parlare anche del Lizard, ma mi allontanerei dal tema, del resto l’ho già fatto in altre sedi. Se differenziare fra intensi e brinati è importantissimo, non lo è altrettanto fra melanici, lipocromici e pezzati; questi ultimi sono di fatto degli intermedi, visto che si parla di razze di forma e posizione, non di colore.
La divisione per colore nelle razze di forma e posizione è secondaria, più che altro serve a dare qualche premio in più, cosa anche comprensibile vista l’importanza di certe razze. Il colore è impor-
Se differenziare fra intensi e brinati è importantissimo, non lo è altrettanto fra melanici, lipocromici e pezzati


tante nelle razze a duplice attitudine, vale a dire colore e forma, dove hanno rilievo entrambi gli aspetti. Una modesta importanza del colore la si rileva considerando che i nero-bruni hanno un piumaggio che tende ad essere più robusto, visto che l’eumelanina rende la penna appunto un poco più robusta. Non a caso le penne più sollecitate nel volo in quasi tutte le specie sono più ricche di eumelanina. I veri pezzati possono avere svariate espressioni: a vote l’estensione dell’acianismo e delle pezzature melaniche è simile, altre volte tende a prevalere l’acianismo, altre volte, e più spesso, la parte melanica. Non parlo, per ora, di macchiati, poiché non sono veri pezzati. L’espressione delle pezzature è ben poco sensibile alla selezione ed abbastanza casuale. Tuttavia non del tutto; infatti si nota una modesta risposta alla selezione stessa; lo si è visto ai tempi dei pezzati simmetrici, ora non più considerati, come attualmente anche nell’Arlecchino portoghese. Ancora oggi nelle razze inglesi si nota una certa frequenza di pezzati simmetrici, ma-








gari parziali, visto che sono apprezzati in Inghilterra.
Un caso strano ma non unico è che, nei pezzati a livello medio, le remiganti primarie sono sempre, almeno in parte, acianiche. Strano per l’importanza delle stesse nel volo e la loro ricchezza naturale di eumelanina. Un caso simile lo si nota nel Piccione. Solo nei pezzati con netta prevalenza della parte melanica si possono avere remiganti primarie quasi tutte melaniche, raramente tutte. Evidentemente nella mutazione acianismo non incidono le esigenze fisiologiche del volo.
Nei macchiati l’espressione delle macchie segue regole non fisse ma frequenti. Nei melanici le macchie acianiche attengono alle remiganti, specialmente primarie ed alle timoniere, specialmente quelle centrali. Altri luoghi sono eccezionali tranne le unghie.
Nei lipocromici, oltre a becco e squame delle zampe, le macchie melaniche appaiono spesso sulla testa, il collare, l’ala, zona ventrale nella parte vaporosa ed il polpaccio. Difficili da notare quelle relegate alla parte vaporosa (il cosiddetto sotto piuma), quelle piccole del polpaccio, specialmente nella parte interna e quelle piccolissime vicino all’occhio, con il cui colore si confondono.
Non ritengo molto utile, tuttavia semplice, differenziare i vari aspetti dei veri pezzati: pezzato, lipocromico pezzato, e melanico pezzato, si tratta comunque di intermedi e si badi a non confondere gli ultimi 2 con i macchiati. Il problema è come gestire le macchie. Premesso e ribadito che, a mio parere, i macchiati non dovrebbero essere considerati pezzati, i mezzi per differenziare non sono molto facili da individuare come descrizione vincolante. Si potrebbe indicare una dimensione massima, non facile da individuare, ad esempio 1,5 o 2 centimetri quadrati, ma sarebbe discutibile, ne ho viste raramente alcune maggiori. Anche il numero massimo delle macchie sarebbe opinabile: 2, 3, 4 o quante? L’importante è non esagerare con le astruse-
Un caso strano ma non unico è che, nei pezzati a livello medio, le remiganti primarie sono sempre, almeno in parte, acianiche
rie, specialmente per gli stamm. Per i melanici la cosa è più semplice: solo penne forti, remiganti e/o timoniere. Eviterei di dare numeri fissi, poco importa che le timoniere siano 1 o 6, così per le remiganti. Non avrebbe molta utilità mettersi a contare, con i problemi di sgabbio.
Su becco e unghie ignorati, non ci sono problemi. Semmai c’è da chiedersi delle piccole macchie melaniche di pochi millimetri che possono sfuggire, specialmente se in parte nascoste: che fare? Per me sarebbero da ignorare, ma ora c’è il rischio che qualcuno le veda ed altri no, capita anche nel colore. Oggi comunque ci si orienta a non accettare alcuna macchia nel piumaggio. Un problema che mi pare da sottolineare, è che con queste divisioni si incoraggiano selezioni inutili a favore di colori puri nelle razze di forma e posizione. Senza pensare alle “tolettature” che probabilmente verrebbero effettuate da alcuni, in caso di macchie piccolissime. Non riterrei opportuno differenziare le diverse mutazioni, di melanine o di carotenoidi, tranne i bianchi. Diverso ovviamente il caso nelle razze a duplice attitudine. Sperando di non essere stato troppo molesto concludo.





•Invitiamo tutti gli allevatori a inviare foto di soggetti provenienti dai propri allevamenti, con descrizione della specie, razza e mutazione, all’indirizzo: redazione@foi.it
•All’autore della foto mensilmente prescelta da un comitato interno, verrà offerto in omaggio un libro edito dalla FOI in base alla preferenza e alla disponibilità.
(*)Tutte le foto inviate, anche quelle non pubblicate, rimarranno a disposizione della FOI a titolo gratuito e potranno essere utilizzate, senza alcun limite o vincolo temporale, per pubblicazioni, iniziative e scopi promozionali della Federazione
Questo mese, il protagonista di Photo Show è:
DEMETRIO PITASI R.N.A. 40DB con la fotografia che ritrae il soggetto:
“Lucherino testa nera ancestrale maschio” (Spinus magellanicus)
Complimenti dalla Redazione!




testo
L’ornitocoltura moderna, per i soci della Federazione Ornicoltori Italiani, si identifica come un connubio indissolubile fra Allevatori e panorama espositivo sportivo, composto dal circuito mostre che ogni anno si organizzano su tutto il territorio nazionale.
Oggi più che mai, non solo in Italia, ma in tutta Europa, l’ornitocoltura ha bisogno di nuovi stimoli e di un rinnovato fermento propositivo per continuare ad affermare i valori e i contenuti che stanno alla base dell’intero movimento ornitologico che ci appartiene e gli attori di questi buoni propositi dovremmo essere tutti noi, nessuno escluso.
Sovente ci nascondiamo dietro falsi pretesti, per addebitare ad altri le cause dei nostri insuccessi. È ovvio che i rappresentanti degli organi tecnici della FOI dovrebbero fornire gli input iniziali che sono necessari a tracciare le direzioni maestre da seguire, per raggiungere gli obiettivi fissati. Ma la base, composta dagli allevatori FOI, dovrebbe rendersi parte attiva in questo cammino che si sviluppa su diversi fronti e che ci coinvolge tutti.
Le cause della sofferenza dell’ornitocoltura europea non sono dovute soltanto alla mancanza di alcuni standard per determinate razze, oppure alla scheda di giudizio che andrebbe riconsiderata. Queste azioni, seppur molto utili, incidono per una frazione centesimale sui risultati ultimi. Il nostro movimento ornitologico, oggi più che mai, ha bisogno di un rinnovato fermento quotidiano, che generi interesse, e gli attori protagonisti di questo percorso dobbiamo essere tutti noi. Immaginiamo una discoteca, che per avere successo necessita di una vasta utenza, che fruisce dei servizi offerti con l’obiettivo primario di riempire la pista. Ognuno di questi protagonisti della scena assumerà a proprio modo un ruolo. Alcuni più bravi e coordinati, altri più scomposti e improvvisati. Però tutti saranno certamente, seppur a modo proprio, protagonisti del risultato raggiunto, che conferisce successo alla struttura danzante.
Questa metafora dovrebbe far intendere che ognuno di noi, seppur nei modi e con mezzi diversi, può contribuire attivamente con il proprio apporto, purché si focalizzi la meta, che deve rimanere la medesima per tutti i protagonisti.
Dal Presidente della FOI, passando poi ai Presidenti di Raggruppamento e a quelli di Associazione e via via anche ai Presidenti di Collegio, di CC.TT.NN. e per finire agli allevatori, ognuno, con azioni diverse ma organiche, può fare tanto: le esposizioni ornitologiche; la divulgazione attraverso piccoli simposi monotematici; giornate di aggiornamento tecnico anche in videoconferenza; incontri tecnici post-giudizio con gli allevatori; sono tutti momenti di aggregazione sociale a sfondo ornitologico che contribuiscono a tenere acceso l’interesse per la nostra passione. Questi momenti di incontro, anche in videoconferenza, andrebbero organizzati almeno una volta al mese, per ogni collegio di specializzazione, per calamitare l’interesse su tutti i fronti a 360°. In tal modo, si sensibilizzano maggiormente gli allevatori, che ritengo siano i protagonisti principali di questa “platea danzante a sfondo ornitologico”, riconoscendo loro il vero merito del successo espositivo per ogni collegio di specializzazione.
Ma dovremmo sviluppare maggiormente anche la consapevolezza di preservare e custodire gelosamente il patrimonio delle nostre mostre ornitologiche, che si svolgono su tutto il territorio nazionale, le quali vengono talvolta snobbate (in primis il Campionato Italiano) a vantaggio di altre mostre fuori confine. Così facendo, seppur in maniera inconsapevole, ci rendiamo partecipi dell’insuccesso dell’ornitocoltura Italiana.
La direzione che il nostro movimento ornitologico sta assumendo la si desume in gran parte dai numeri espositivi e dalla loro qualità espositiva. Il nostro collegio EFI, nel contesto FOI-Italia, ha assunto un ruolo da protagonista, i numeri ci danno ragione, attestandoci con una crescita di oltre il 20% rispetto all’anno precedente.

Attualmente, ogni 100 soggetti esposti al Campionato Italiano, 47 sono del Colore; 19 sono degli EFI; 16 sono dei Lisci; 9 sono dei Pappagalli, 5 sono degli Arricciati e 4 sono del Canto (dati desunti sulla base dell’ultimo Campionato italiano di Montichiari, anno 2024).
Molto apprezzati ed incoraggianti sono stati i numeri espositivi registrati durante l’ultimo Campionato Italiano di Montichiari 2024 sia a livello globale che per singole sezioni. Ma le maggiori soddisfazioni le abbiamo ottenute dagli Ibridi, dove forse l’innovazione rispetto al passato è stata maggiormente incisiva (Ibridi esponibili per sempre, esponibilità degli Ibridi intragenere, nuove categorie dedicate agli Ibridi di sesso femminile, esponibilità degli Ibridi pezzati, Ibridi con il Canarino diverso dal Canarino di Colore, categorie a concorso ben ordinate e suddivise per tipologia e razza).
Queste scelte di cambiamento sono state ben apprezzate dagli allevatori a tal punto che ci hanno regalato buone soddisfazioni, grazie agli incrementi numerici espositivi che abbiamo registrato rispetto al passato:
•88 Ibridi esposti nella sezione FH, +60% rispetto al precedente Campionato Italiano di Lanciano 2023
•586 Ibridi esposti nella sezione GH, +39% rispetto al precedente Campionato Italiano di Lanciano 2023 (di fatto, gli ibridi all’interno della sezione GH da soli rappresentavano il 24% del totale dei soggetti EFI esposti)
Il Diamante di Gould, invece, è stata la specie più esposta all’ultimo Campionato Italiano 2024 di Montichiari con 184 soggetti.
Un dato significativo lo abbiamo registrato anche a carico degli individui appartenenti alla famiglia dei Turdidae , in particolar modo Merlo, Tordo bottaccio e Tordo sassello (specie largamente allevate anche dal fenotipo mutato ed esposte anche con più stamm a concorso durante l’ultimo Campionato Italiano 2024 di Montichiari con una soddisfacente presenza di 49 soggetti)
Anche per il Serinus canaria (Canarino selvatico) abbiamo registrato una crescita numerica rilevante dei soggetti in ambito espositivo. La specie risulta infatti largamente allevata ed esposta oramai su tutto il territorio Italiano e soltanto con il fenotipo classico, visto che abbiamo

espressamente vietato l’esposizione in mostra delle mutazioni del piumaggio, così come sono stati vietati in esposizione gli Ibridi con il Canarino selvatico. Durante l’ultimo Campionato Italiano c’è stata una soddisfacente presenza di soggetti a concorso, con 13 Stamm e 23 soggetti singoli esposti, per un totale di 75 soggetti in un’unica categoria a concorso. Ed anche nelle due mostre specialistiche di Fringillia ed Hornemanni nel 2024 (ove ho avuto il privilegio di far parte della giuria) sono stati esposti rispettivamente 65 e 21 soggetti.
Ma il dato che maggiormente abbiamo apprezzato durante l’ultimo Campionato Italiano di Montichiari 2024 è stato quello globale.
Su 12672 soggetti esposti fra tutte le sezioni a concorso, 2439 (cioè pari al 19.25 %) sono stati soggetti EFI. Con un più che apprezzabile incremento del 16,31% rispetto al precedente Campionato Italiano di Lanciano 2023.
Dato che ci ha permesso di balzare al secondo posto dopo il Colore (peraltro, per il secondo anno consecutivo) nella classifica dei soggetti esposti al Campionato Italiano.
Ma attenzione!
Il dato più importante di questo successo del nostro collegio di specializzazione EFI non è tanto che siamo cresciuti a discapito degli altri collegi. NO! Siamo cresciuti perché ci sono più allevatori che allevano EFI.
Infatti, abbiamo potuto constatare che quasi tutti gli allevatori FOI, che allevano prioritariamente Colore, Lisci, Arricciati o Pappagalli si dilettano spassionatamente ad allevare anche EFI e principalmente Ibridi.
Una raccomandazione voglio farla agli allevatori italiani e che faccio pure mia: quando c’è una mostra nei paraggi, anche soltanto un soggetto, esponetelo. E quando arriva il momento del Campionato Italiano, partecipate!
In tal modo avrete contribuito a dare valore al concorso espositivo ornitologico più importante in Italia.
E se dovesse venirvi in mente di non andare per preservare i soggetti per una mostra come il Mondiale, sappiate che due mostre, a distanza di 30 giorni, si possono sempre fare, magari alternando alcuni soggetti da esporre.
In tal modo, una parte del successo ornitologico italiano sarà stato pure merito vostro.









Troglodytes troglodytes
testo di DINO TESSARIOL, foto AUTORI VARI
Quasi cinquant’anni fa, quando venimmo ad abitare sul Montello, mia moglie, abituata alla zona residenziale, iniziò fin da subito a disperarsi per la gran quantità di ragnatele che si accumulava sull’esterno delle finestre e mi chiese cosa potesse fare per eliminarle una volta per tutte; era il mese di ottobre ed io le dissi di aspettare, che qualcuno sarebbe sicuramente venuto a far la pulizia dei ragni; lei non capì, ma mi ascoltò e non fece le pulizie esterne. Passarono soltanto alcuni giorni ed un mattino rimase incredula vedendo lo Scricciolo che passava a setaccio finestra per finestra e così fu anche per i giorni successivi; da allora, le nostre finestre sono diventate la meta preferita del mangiatore di ragni, che in tutte le stagioni si alimenta abbondantemente degli arac-
Lo Scricciolo è un uccellino molto curioso, tanto che deve assolutamente rendersi conto di ogni novità che succede all’interno del suo territorio
nidi che si accumulano sulle nicchie del muro, dandoci la possibilità di assistere ad uno spettacolo unico. Lo Scricciolo è un uccellino molto curioso, tanto che deve assolutamente rendersi conto di ogni novità che succede all’interno del suo territorio ed io, conoscendolo, ho sfruttato molto spesso questo lato del suo carattere.


Per diversi anni, prima delle sette del mattino portavo mia figlia giù in paese a prendere la corriera degli studenti e d’inverno, quanto tornavo a casa, iniziava ad albeggiare. Io parcheggiavo la macchina, abbassavo un po’ il finestrino e battevo qualche colpetto con le dita sulla porta: non passava un minuto che lo Scricciolo veniva a posarsi sullo specchietto retrovisore esterno per controllare cosa ci fosse di nuovo che lui non conosceva e così io, lì a mezzo metro, me la godevo da matti. Chi poi ha la passione della fotografia ed ha montato un capanno mimetico dove rifugiarsi, potrà confermare che qualche minuto dopo lo Scricciolo appare sulla fessura del telo per sincerarsi della novità.
In Svizzera è stato designato “uccello dell’anno 2012”. Il suo nome evoca-

tivo, il suo aspetto audace e la sua minuscola taglia fanno dello Scricciolo una delle nostre specie di uccelli più popolari e conosciute.
Sto parlando del più piccolo uccello d’Europa assieme al Regolo ed al Fiorrancino: lungo dai 9 ai 10 cm e mezzo, con un’apertura alare che va dai 13 ai 17 cm e con un peso che al massimo arriva a 10 grammi, ha forma arrotondata a palla paffuta, con testa molto grande rispetto al corpo e becco sottile ed abbastanza lungo che sporge nettamente dal profilo della testa; ala relativamente ampia, larga, corta e di forma ovale, coda molto corta e, eccetto quando vola, tenuta costantemente all’insù. Il piumaggio è di un marrone grigiastro scuro di tonalità calda, le parti inferiori sono camoscio brunastro chiaro, marrone più scuro nella parte posteriore e nelle copritrici sottocaudali; le timoniere e le remiganti marroni sono finemente barrate di camoscio. Le lunghe zampette sono provviste di dita altrettanto lunghe, dotate di forti artigli, con i quali riesce ad arrampicarsi agevolmente anche su tronchi d’albero. È possibile distinguere gli esemplari maschi dalle femmine unicamente in base al comportamento, in quanto cantano solo

Il volo è veloce e diretto, piatto e leggermente ondulato, con battiti d’ali rapidi e ronzanti; di solito vola basso e tende a rimanere nascosto tra la vegetazione


i maschi e covano solo le femmine. I suoi nemici che si trovano a terra vengono scacciati cantando a squarciagola. All’avvicinarci di un pericolo proveniente dal cielo, lo Scricciolo si rifugia invece in un nascondiglio sicuro.
Il volo è veloce e diretto, piatto e leggermente ondulato, con battiti d’ali rapidi e ronzanti; di solito vola basso e tende a rimanere nascosto tra la vegetazione, nelle cataste della legna o nei mucchi di ramaglia lasciati nel sottobosco, con l’abitudine di essere maggiormente attivo al crepuscolo e nelle ore precedenti l’alba. Agile, dinamico e scattante si muove con destrezza accorrendo in ogni luogo o verso ogni oggetto che catturi la sua attenzione. Ama muoversi sul terreno, ispezionando tutto ciò che lo colpisce. L’interesse a qualsiasi novità è infatti una prerogativa fondamentale di questo piccolo passeriforme, che vola di cespuglio in cespuglio e saltella sul terreno con grande abilità, tanto da assomigliare spesso a un piccolo mammifero. Sia che esso si trovi in una foresta oppure nelle vicinanze degli insediamenti umani, lo Scricciolo si sente a proprio agio, a condizione che il suo habitat sia ca-



ratterizzato da un certo “disordine”. In genere è facile osservarlo all’interno del sottobosco. La sua ridottissima mole non gli impedisce di essere un uccellino alquanto chiassoso, richiamando su di sé l’attenzione soprattutto grazie al suo canto squillante con una voce potente che non si direbbe provenire da minuscolo uccellino; il canto dello Scricciolo può essere udito fino a una distanza di 500 metri ed è costituito da una serie di trilli prolungati e molto musicali che, alla distanza di un metro, raggiungono una potenza di ben 90 decibel. Il più delle volte si nasconde nel fitto del sottobosco e si sposta piuttosto saltellando che volando attraverso i cespugli e le cataste di ramaglia; predilige folte siepi e la presenza di legno morto caduto a terra nel bosco.
Lo Scricciolo annovera numerose sottospecie diffuse tra il Nord America, l’Europa, la Russia, il Giappone, nella fascia tra le coste del Mare del Nord e nel Mar Baltico fino alle Alpi e ai Carpazi. Nell’Europa centrale ha indole piuttosto sedentaria ed è un migratore facoltativo. Gli Scriccioli che vivono nella Scandinavia, nei Paesi Baltici e in Russia migrano in autunno verso regioni più calde, analogamente alle popolazioni delle foreste alpine, che tendono a spostarsi verso le quote più basse. Grazie alla tecnica delle catture ripetute è stato dimostrato che lo Scricciolo, nonostante le sue piccole dimensioni, sia capace di coprire in volo distanze da 40 a 50 chilometri al giorno. Il record per la più lunga distanza percorsa in volo da uno Scricciolo è testimoniata da un uccello inanellato a Gotland in Svezia e che in seguito è stato ritrovato nel sud della Spagna, a 2.800 km di distanza. In Italia è nidificante, di passo e svernante. Lo Scricciolo si trova bene in diversi habitat, ma ha comunque una preferenza per i boschi misti o di latifoglie ricchi di vegetazione e sottobosco nei quali l’umidità del suolo è elevata. La presenza di legno morto è importante, tenuto conto che esso ama costruire il proprio nido all’interno di cataste di ramaglia, nei sistemi radi-

cali di alberi sradicati oppure tra i rami o nelle cavità di tronchi d’albero e di ceppaie. Se si lascia un angolo di habitat naturale all’interno del proprio giardino, non è raro riuscire ad osservare lo Scricciolo anche all’in-
terno delle aree abitate. Mentre in primavera e in estate lo Scricciolo vive soprattutto all’interno delle foreste, durante l’inverno molti individui di questa specie tendono a cambiare il proprio habitat. Diversi cercano degli ambienti acquatici, dove anche nella stagione fredda possono trovare insetti in grande quantità. Molto apprezzate in inverno sono ad esempio le paludi, soprattutto dove sono presenti dei canneti, ma è possibile osservarlo anche nelle aree abitate, come nei pressi dei siti di compostaggio, dove riesce a trovare di che nutrirsi. Al fine di mantenersi al caldo durante le fredde notti invernali, spesso si raggruppa in comunità di una decina di uccelli che si scaldano l’un l’altro. A tale scopo essi si dispongono in cerchio, mantenendo le teste allungate verso il centro del gruppo e le code verso l’esterno. Sono stati osservati dei giovani che in inverno dormivano dentro ammassi di piume o all’interno di edifici o anche ammassati insieme per tenersi caldo l’uno con l’altro. Fu proprio durante una notte gelida che, in Inghilterra, furono visti ben 61 scriccioli entrare in una cassetta nido e al mattino ne uscirono tutti salvi. Se l’in-







verno è particolarmente rigido anche i maschi, che di solito sono particolarmente aggressivi nella difesa del loro territorio, tendono a tollerare la presenza di altri esemplari.
La stagione degli amori inizia in aprile e dopo la colonizzazione del territorio i maschi iniziano a costruire diversi abbozzi di nido, all’interno dei quali cercano di attirare le femmine tramite il proprio vigoroso canto; come materiali da costruzione essi utilizzano muschio, foglie secche, steli, rametti e piccole radici allo stato umido, cosicché indurendosi, quando diventano secchi, conferiscono la necessaria resistenza all’intero nido. I nidi di forma sferica assomigliano a dei “forni per cuocere il pane” e si trovano di solito nei pressi del terreno, tra la vegetazione folta, oppure tra le ceppaie di alberi caduti o sotto alle radici di ceppaie erose dall’acqua situate lungo le sponde dei corsi d’acqua. Più volte al giorno il maschio ispeziona i propri nidi, difendendo il territorio dall’arrivo di altri maschi. Un solo maschio deve possedere almeno due o tre nidi per offrire una scelta sufficientemente ampia e riuscire ad attirare almeno una femmina, ma a volte sono necessari fino a 12 nidi.
Se una femmina si avvicina, il canto del maschio diviene più fluido e tranquillo, per poi divenire quasi solo un leggero bisbiglio
Se una femmina si avvicina, il canto del maschio diviene più fluido e tranquillo, per poi divenire quasi solo un leggero bisbiglio. Il maschio presenta alla femmina uno dei nidi, volando al di sopra di esso e infilandovi dentro la propria testa, mentre sta cantando. Solo quando la femmina mostra il proprio interesse verso il nido prescelto avviene l’accoppiamento. Da questo momento in poi, è la femmina che si occupa del nido, rivestendone l’interno con piume, muschio, peli o lana e deponendovi da 5 a 7 minuscole uova che pesano poco più di 1 grammo. Il maschio successivamente non si occupa più della prole in quanto impegnato ad attirare ulteriori femmine nel proprio territorio,
allo scopo di offrire loro un nido adeguato; lo Scricciolo tende ad essere poligamo, a patto che le condizioni di approvvigionamento in termini di cibo e la qualità dell’habitat lo permettano. Da 13 a 15 giorni dopo, i piccoli fuoriescono dal guscio, rimanendo poi ancora 19-20 giorni all’interno del nido, prima di involarsi. Il maschio tende a trattenersi prevalentemente nei pressi del nido, anche se alimenta la femmina solo raramente. Durante la fase di involo i piccoli uccellini vengono di solito accompagnati dal maschio. La coppia rimane unita volando e pernottando insieme in uno dei nidi prescelti ancora al massimo per 18-20 giorni dopo che i giovani hanno abbandonato il nido. In genere, dopo un accoppiamento coronato da successo, nel mese di giugno viene allevata una seconda covata.
Dotato di un becco piuttosto appuntito e leggermente ricurvo, lo Scricciolo si nutre di insetti, bruchi, vermi e piccoli ragni, opilionidi, falene, mosche e altri insetti che trova sulle foglie; in inverno non disdegna qualche bacca.
In Europa le popolazioni dello Scricciolo non sono attualmente minacciate; tuttavia, inverni molto rigidi possono provocare importanti perdite, che comunque di solito sono recuperate nel giro di pochi anni. La qualità degli habitat dello Scricciolo tende comunque a diminuire costantemente, poiché i giardini sono sempre più sterili, mentre le foreste divengono strutturalmente più povere a seguito dei diradamenti selettivi. Con pochi semplici provvedimenti sarebbe tuttavia possibile rimediare, osando un po’ e, ad esempio, trasformando i nostri giardini in piccoli paradisi naturali, magari accatastando mucchi di rami o creando recinzioni composte da rami, lasciando un po’ incolte le siepi e favorendo un sottobosco fitto e ricco di arbusti autoctoni come il sorbo, il biancospino, il prugnolo o il sambuco. Anche nel bosco lo Scricciolo approfitta, insieme a molti altri animali, del motto “meno sforzo è meglio”; cataste di legna e ramaglia, alberi caduti o morti ma an-

cora in piedi, lasciati intatti, oltre che terreni umidi, offrono allo Scricciolo condizioni ideali per nidificare e nutrirsi. Boschi simili allo stato naturale e ricchi di legno morto sono, peraltro, di notevole importanza per la loro biodiversità.
Il suo allevamento in ambiente controllato credo sia tra i più difficili tra gli uccelli insettivori, ma da giovane avevo un amico che era riuscito ad abituarlo a nutrirsi dei pastoncini per insettivori ed in voliera un esemplare era vissuto quasi dieci anni; come altri uccelli è protetto, ne è vietata la caccia e la detenzione se non proveniente da allevamento autorizzato, con apposizione di anello inamovibile nei primi giorni di vita, cosa che garantisce la certezza della regolarità del soggetto.
Concludo con questa favoletta che può significare quanto la forza pura non sia sempre vincente, come spesso siamo portati a credere:
Secondo una favola del narratore greco Esopo (600 a.C.) gli uccelli decisero di coronare loro Re quello che era in grado di volare più alto. Un furbo Scricciolo si nascose tra le piume di un’aquila e, quando quest’ultima volò più in alto degli altri uccelli, il piccolo Scricciolo uscì dal suo dorso e iniziando a sovrastarla gridò: “Io sono il Re!”. Infuriati, gli altri uccelli lo segregarono nella tana di un topolino, dalla quale lo Scricciolo riuscì tuttavia a fuggire di nuovo. Da allora, esso vive nel sottobosco, pur essendo diventato il Re del creato.
Versioni simili della favola dedicata a questo regale uccellino esistono in diverse lingue. I fratelli Grimm ripresero peraltro questo racconto nel 1812, abbellendolo ed integrandolo nella loro raccolta di fiabe.
I Grimm ripresero questo racconto nel 1812, abbellendolo ed integrandolo nella loro raccolta di fiabe.





testo di FRANCESCO DI GIORGIO, foto G. MARSON

Ciò che più stupisce, nel canto del canarino, è la notevole varietà di gorgheggi e di trilli, l’agilità con cui il piccolo artista si arrampica sulle più ardue vette del pentagramma, la ricchezza dei registri: si direbbe che non un semplice istinto, ma un vero genio canoro, un illuminato desiderio di armonia animi il minuscolo uccellino.
Io anticipo di qualche mese la stagione degli amori dei miei canarini affinché la prole sia competitiva nel canto sin dai primi di novembre.
Maschi e femmine, prima degli accoppiamenti, ricevono un’alimentazione più ricca del solito e luce artificiale supplementare, che contribuiscono ad aumentare l’estro amoroso.

La femmina, nell’isolamento della sua gabbia, dopo che ha costruito gran parte del nido, non è insensibile all’appassionata corte del maschio.
La fecondazione avviene quando questo rimane appollaiato sulla schiena della compagna.
In questa posizione i due animali, curvando la coda, mettono in contatto le rispettive cloache.
Gli spermatozoi passano direttamente dal maschio alla femmina.
In teoria sarebbe sufficiente una sola copula per fecondare tutto il grappolo ovarico, ma è bene far ripetere l’accoppiamento il giorno successivo e sostituire con uova finte quelle che non vanno veramente deposte.

A deposizione ultimata le si riunisce, dando così inizio allo sviluppo dell’embrione e poi alla nascita pressoché simultanea dei nidiacei dopo circa due settimane di cova. L’allevamento dei pulli è riservato così alla sola madre, molto attiva e precisa nelle imbeccate, cui è opportuno risparmiare la fatica di un secondo ciclo riproduttivo. Durante l’allevamento bisogna curare in modo particolare l’alimentazione somministrando cibi adeguati freschi e vigilare sulla salute dei novelli (isolando immediatamente quelli che necessitano di cure), prevenendo le malattie con una costante pulizia dell’ambiente e arieggiandolo senza creare sbalzi eccessivi di temperatura.

Nella selezione dei canarini da canto l’apparato respiratorio deve essere perfetto perché anche una leggera tracheite durante la crescita dei piccoli verrebbe contagiata con l’imbeccata e si rischierebbe una prole inadatta al canto. Negli accoppiamenti dei miei Malinois scelgo soggetti con collo lungo e petto largo (efficienza respiratoria e vigoria fisica) e continuo in questa selezione perché con essi ottengo elementi molto validi e capaci di emettere un canto melodioso e con tono profondo e sonoro. Nel nostro canarino esistono vari indirizzi di canto ma quelli maggiormente apprezzati e ricercati sono due: l’indirizzo usignolato metallico e quello d’acqua. Quando i novelli crescono in salute ci danno gioia, ci fanno sognare, ed è un piacere sentirli nella vivacità con i loro inizi canori, dove manifestano la loro predisposizione al canto e attendono poi che gli istruttori alati si pronuncino per poterli imitare.
Durante l’allevamento bisogna curare in modo particolare l’alimentazione
Per me è il massimo sentire nel novello la Klokkende prima che inizi la scuolacanto.
Alla confluenza delle spinte prodotte dall’ereditarietà e dall’ambiente si erge il canarino campione di canto, fiore all’occhiello della razza e dell’espositore. Sulla validità canora d’un soggetto –orientativamente – l’ereditarietà influisce nella misura del 60%, l’addestramento nella misura del 25% e l’attività ormonale del 15%.
È difficile ottenere il tipo di canto otti-
male, cioè le melodie caratteristiche d’acqua e quelle usignolate di primo piano fuse insieme.
Esso tanto più si conserva quanto più i soggetti provengono da ceppi di alta selezione.
Ma non basta possedere cantori di primo piano.
Alimentarli appropriatamente (direi spartanamente) e alloggiati con poca luce (fuorché durante l’allevamento della prole e la muta del piumaggio) è una questione analoga a quella che riguarda l’uso dei coloranti nei Sassoni. Ha scritto in un libro Marina Roberti: “Il canarino di pregio fa della sua voce uno strumento che manovra con grande perizia dosando le cadenze, le pause, le riprese, gli acuti, le note basse; dedica il suo canto a chi gli sta vicino e chi lo ascolta non può fare a meno di chiedersi come tanta dovizia di suoni, caldi, prolungati, impetuosi possa uscire da un tale esserino”.














testo e foto di DIEGO CATTAROSSI (*)
L’allevamento degli uccelli da gabbie e voliera, che si parli di canarini, di esotici, di indigeni, di pappagalli o di columbiformi e galliformi, è sempre più spesso reso difficile per la diffusione di malattie infettive. In questo breve scritto vorrei dare alcuni spunti di riflessione sulle più pericolose malattie dei nostri amati uccelli, perché solo dalla conoscenza del problema possono nascere un giusto approccio ed un tentativo di soluzione o di gestione.
Chi alleva uccelli da molti anni potrà testimoniare che la comparsa e diffusione di malattie vecchie o nuove nell’allevamento ornitologico è sempre stata un’evenienza possibile e temuta. È però sentire comune che in questi anni la diffusione di malattie, spesso mai segnalate nelle specie nelle quali si presentano, abbia assunto dei connotati preoccupanti in termini di frequenza di comparsa e di gravità dei sintomi. Alcune malattie possono mettere a repentaglio l’intera produzione ornitologica dell’anno, a volte compromettere l’allevamento stesso, con la perdita dei riproduttori e dell’entusiasmo da parte dell’allevatore.
Ci sono diversi motivi per l’attuale maggiore suscettibilità dei nostri allevamenti all’aggressione da parte di patogeni gravi o mortali. Solo per citarne alcune, tra le cause che più comunemente contribuiscono all’insorgenza e diffusione delle malattie infettive pos-

Ci sono diversi motivi per l’attuale maggiore suscettibilità dei nostri allevamenti alla aggressione da parte di patogeni gravi o mortali
siamo citare l’indebolimento dei ceppi genetici attraverso l’abuso dello strumento della consanguineità; la ricerca di fenotipi estremi e molto lontani da quello ancestrale; l’utilizzo di un’alimentazione non corretta o di scarsa qualità; la partecipazione a mostre e lo scambio di soggetti tra allevatori; la mancanza di quarantena e profilassi igienico sanitarie in allevamento; i cambi climatici con temperature ed umidità estreme; la presenza di insetti ematofagi come le zanzare durante

(*)Clinica Veterinaria “Casale sul Sile” www.veterinariacasalesulsile.com




tutto l’anno; la perdita nel commercio di molecole e farmaci utili per la prevenzione e cura della malattie.
Questi ed altri fattori permettono la rapida diffusione di agenti patogeni, per alcuni dei quali, purtroppo, non abbiamo ad oggi una cura efficace. L’arma migliore in questo senso resta sempre la prevenzione, la riduzione del rischio di contagio, la gestione tempestiva e mirata del problema sin dai primi segni di insorgenza della malattia in allevamento. Non mettiamo mai “la testa sotto la sabbia”, se in allevamento si presenta un problema di salute va sempre indagata la causa e cercata la terapia.
Le norme cardine per la prevenzione di tutte le malattie restano sempre le stesse, ovvero introdurre nuovi soggetti in allevamento solo se strettamente necessari; isolare in quarantena i nuovi soggetti per un periodo sufficiente per valutare l’eventuale comparsa di sintomi di malessere; eseguire
L’arma migliore in questo senso resta sempre la prevenzione
esami diagnostici presso veterinari specializzati con routine regolare e per tutti i nuovi arrivati; isolare i soggetti al rientro dalle competizioni e fiere per valutare la possibile insorgenza di sintomi di avvenuto contagio; rispettare in ogni fase dell’allevamento le più rigorose norme igieniche, di pulizia, di detersione e disinfezione di ogni attrezzattura ed utensili; curare la qualità dell’aria ed impedire il contatto con insetti, uccelli selvatici e roditori; fornire un’alimentazione corretta ed igienicamente ineccepibile; stimolare le difese immunitarie dei nostri uccelli con appositi integratori. Evitiamo sempre il
“fai da te”, le diagnosi “per sentito dire”, le terapie date “a caso”. Cerchiamo sempre di avere un approccio scientifico, ovvero approfondire le cause del malessere dei nostri animali in modo oggettivo, per fornire loro la miglior cura disponibile.
La grande sfida veterinaria dei nostri tempi in ambito ornitologico consiste principalmente, anche se non esclusivamente, nelle infezioni di natura virale. I virus sono agenti patogeni di diversa natura, spesso molto contagiosi e pericolosi, che hanno in comune due aspetti molto negativi: sono difficili da diagnosticare con i comuni esami eseguibili in ambulatorio e sono difficili da eradicare per la scarsa disponibilità di farmaci antivirali.
I comuni esami delle feci ed i tamponi eseguiti per esami batteriologici ed antibiogramma non sono metodi sufficienti o utili per poter formulare una diagnosi di infezione virale. Servono degli esami specifici che il medico veterinario potrà consigliare sulla scorta del sospetto diagnostico. Alcuni esami (PCR) possono essere eseguiti partendo da tamponi specifici eseguibili sempre da gozzo-cloaca-fessura palatina-feci. In questo caso, però, è necessario avere un sospetto molto circoscritto sui virus da cercare. In alternativa, la diagnostica istologica (parti di tessuti dell’animale) può darci importanti informazioni su eventuali infezioni virali, ma va fatta sui tessuti, quindi richiede spesso la presenza di un soggetto deceduto. È questo il motivo per il quale non bisognerebbe mai gettare un soggetto che venga a morire in allevamento, perché è dal cadavere che sarà possibile arrivare ad una diagnosi certa per cercare di salvare gli altri soggetti. Per essere utile ai fini diagnostici, il corpo del soggetto deceduto deve essere conservato a temperatura di frigorifero e conferito al medico veterinario specialista nell’arco di 24 ore; se questo non fosse possibile, il corpo va messo in congelatore e conferito al veterinario appena possibile. Il corpo refrigerato è sempre molto più utile del corpo congelato per la realizzazione degli esami diagnostici di laboratorio, in modo particolare per gli esami citologici ed istologici.

L’approccio ad una infezione virale in allevamento è sempre poliedrico e si concentra su riduzione del contagio, stimolazione delle difese naturali dei soggetti, interruzione –quando possibile –del ciclo vitale del virus, identificazione ed eliminazione delle infezioni secondarie indotte dal virus (es. batteriche, protozoarie, micotiche, ecc.), disinfezioni straordinarie con molecole efficaci contro i virus, blocco degli ingressi ed uscite degli uccelli dall’allevamento. Chiunque abbia un’infezione in corso in allevamento, oltreché cercare di curare il proprio aviario, deve impedire che altri colleghi subiscano lo stesso incubo, guardandosi bene dal cedere soggetti ad altri allevatori o partecipare ad eventi, mostre-scambio, fiere del settore.
Facciamo alcuni esempi di malattie virali nell’allevamento degli uccelli. Nei Passeriformi abbiamo avuto in questi anni una forte diffusione di Circovirus (“puntino nero” ed immunodepressione grave) e Polyomavirus (emorragie nei pulli e giovani ed immunodepressione) in fase di allevamento. Il Poxvirus, responsabile del Vaiolo, si ripresenta ogni anno con picchi di morbilità a fine estate-autunno, complice anche l’assenza sul commercio italiano della vaccinazione dedicata ai canarini. Le presentazioni dei Vaiolo si sono in questi anni arricchite di nuovi quadri sintomatologici, come la “placca subgulare” e la sindrome della “lingua gonfia”. Restano sempre molto diffuse le presentazioni classiche: polmonari, difteriche e di crostosità cutanee.
L’approccio
ad una infezione virale in allevamento è sempre poliedrico e si concentra su riduzione del contagio, stimolazione delle difese naturali dei soggetti
Nei Pappagalli sono sempre molto presenti il Circovirus (responsabile della malattia del becco e delle penne - PBFD-) e il Polyomavirus (emorragie ed immunodepressione – APV -). Per queste malattie sono disponibili presso diversi laboratori test diagnostici che sono eseguibili ai soggetti appena acquistati, prima di immetterli in allevamento. Tra i virus emergenti, il Bornavirus (ABV - potenzialmente responsabile della ganglioneuriteproventricolite dilatativa – PDD -). L’Herpesvirus (malattia di Pacheco) può causare epatiti necrotiche letali con decorso molto rapido. Nell’allevamento dei Galliformi ornamentali, anche a causa della difficoltà a reperire vaccini efficaci (per il bisogno di conservarli in azoto liquido), è sempre molto presente ed invalidante l’Herpesvirus responsabile della malattia di Marek. Molto presenti in animali non vaccinati anche

Laringotracheite contagiosa, Adenovirus, Paramyxovirus. Tra i Columbiformi, molto diffusi soprattutto tra i viaggiatori il Circovirus (Young pigeon disease), l’Herpesvirus, l’Adenovirus e il Paramyxovirus. Tutti gli uccelli, appartenenti a qualsiasi gruppo tassonomico, possono essere soggetti a infezioni virali potenzialmente trasmissibili all’uomo (antropozoonosi), come l’influenza aviare (Orthomyxovirus) e la Malattia di Newcastle (Paramyxovirus). Massima prudenza va quindi posta in casi sospetti ed è sempre consigliabile consultare l’Istituto Zooprofilattico Sperimentale competente per territorio in casi sospetti, per poter eseguire una diagnostica certa ed ufficiale per le malattie in questione. Altra malattia gravissima di natura protozoaria e non virale, molto diffusa in Italia tra i canarini e silvani, è la Atoxoplasmosi, che ho già trattato in questa rivista in altro articolo, al quale si rimanda per approfondimento.
Per domande riguardanti la salute dei vostri animali, potete scrivere al dr. Diego Cattarossi alla sua mail: diego.cattarossi@veterinaricasalesulsile.com
Potete seguire il dr. Diego Cattarossi sui suoi canali social: Instagram: Diego.cattarossi.veterinario Facebook:
Clinica veterinaria Casale sul Sile YouTube: Diego Cattarossi
LUCHERINO DORSO NERO
LUCHERINO DI YARRELL
Grande qualità • Ottimi riproduttori BRUGHERIO (MB) Tel. 347.0784494










testo e foto di RAFAEL ZAMORA PADRÓN (*)
Svezzare i pappagalli appena nati dai genitori può essere una vera sfida, ed è ancora più complesso farlo correttamente quando vengono allevati a mano.
A differenza dei passeriformi, che si sviluppano molto rapidamente nella maggior parte dei casi e diventano indipendenti in poco più di un mese, questa fase è più complessa e prolungata nei pappagalli, che richiedono apprendimento sociale e vari stimoli.
Ogni specie di pappagallo ha esigenze diverse e non tutti gli esemplari raggiungono con successo l’indipendenza al momento desiderato. Saper aspettare, prendere decisioni tempestive o scegliere il momento giusto per fare un passo indietro nel processo sono tutti aspetti di questa fase dell’allevamento degli psittacidi. In natura, la separazione dai genitori avviene solitamente quando questi riducono le loro scorte di cibo e costringono i piccoli a seguirli fuori dal nido. In questa fase, alcuni novelli hanno difficoltà perché non riescono a saltare fuori dal nido o vengono attaccati dai predatori, essendo in condizione di particolare vulnerabilità. Solo i più forti della covata sopravvivono a questa fase e il tasso di successo non è così alto come potremmo pensare in natura.



(*)Direttore Scientifico Fondazione Loro Parque




Alcuni novelli
hanno difficoltà perché non riescono a saltare fuori
dal nido o vengono attaccati dai predatori
Con le cure umane, questi risultati possono essere migliorati e, in casi particolari, è necessario fare una distinzione tra i processi di allevamento condotti dai genitori e l’allevamento manuale. Nel primo caso, i genitori di solito si comportano come in natura e incoraggiano i piccoli a lasciare il nido e iniziare a nutrirsi da soli. Tut-



tavia, in alcune specie, il maschio può entrare in conflitto con i pulcini non appena questi lasciano il nido. Gli allevatori devono essere consapevoli dei comportamenti eccessivamente territoriali ed essere preparati a decidere quando è il momento migliore per separare i genitori.
Separare i pulcini con una rete a maglie visibili o in una gabbia interna può prevenire l’aggressività e consentire ai genitori di continuare a nutrirli dall’esterno finché non saranno in grado di nutrirsi autonomamente.
Esistono altre situazioni in cui i genitori devono essere separati senza contatto visivo tra la prole e i genitori, che stanno iniziando una nuova covata. Queste sono le situazioni più complesse, soprattutto con pulcini che non hanno la stessa età, e i più giovani potrebbero aver bisogno di assistenza per iniziare la loro emancipazione.
Per chi è allevatore di pappagalli alle prime armi, questi sono momenti di preoccupazione che richiedono molta osservazione, pratica e apprendimento. Pertanto, non bisogna lasciarsi frustrare da risultati indesiderati.
Quando i pulcini devono essere allevati a mano come metodo ausiliario, perché i genitori non sono in grado di covarli o allevarli da soli, la fase di emancipazione è solitamente più lunga rispetto all’allevamento naturale. Tuttavia, dipenderà in gran parte dall’allevatore garantire che questo processo venga eseguito al momento giusto per non indebolire il giovane pappagallo.
È importante che, quando i pulcini allevati a mano vengono ancora nutriti con pappa, una volta che hanno sviluppato le piume, inizino ad avere un contatto visivo con il cibo. Dovrebbero anche avere un contatto diretto con frutta e verdura. Anche se non riescono a mangiarli, ci giocheranno e svilupperanno la loro naturale capacità di giocare con il cibo tra il becco e la lingua. Questa pratica è molto importante, soprattutto nelle specie di grandi dimensioni come i grandi ara e tutti i cacatua, che richiedono più mesi di lavoro prima di diventare indipendenti.
Il concetto alla base in questa fase dell’allevamento a mano è quello di imitare la natura riducendo gradualmente le poppate e incoraggiando i giovani a mangiare il proprio cibo, tenendo conto dei seguenti punti:
-Un pappagallo isolato diventa indipendente più tardi rispetto a uno accompagnato da fratelli o pappagalli di specie simili, dove la competizione stimola i comportamenti naturali.
Esistono altre situazioni in cui i genitori devono essere separati senza contatto visivo tra la prole e i genitori, che stanno iniziando una nuova covata
-È importante iniziare il processo di emancipazione anche se il pulcino chiede insistentemente cibo. Prima iniziano a mangiare da soli, migliore sarà la loro salute in futuro.
-È utile affiancare un esemplare indipendente allevato dai genitori a quelli che ancora stanno diventando indipendenti. La sola presenza di questo esemplare avrà un’influenza positiva sui progressi dei suoi compagni.
-Schiacciare i semi con il guscio incoraggerà i giovani uccelli a imparare ad aprirli.
-Lo spazio per i giovani uccelli nella fase di indipendenza dovrebbe es-



sere ampio, pulito e fornire stimoli al movimento. Il movimento li incoraggia a nutrirsi e a smettere di chiamare cibo.
Al Loro Parque molti esemplari stanno attraversando questo processo e ognuno deve essere attentamente osservato per monitorarne i
progressi e apportare modifiche se necessario. È importante ricordare che questa fase è cruciale per il loro futuro sviluppo sano.





Nuova specie ibrida scoperta in Texas, la “ghiandaia grue”
Per la prima volta è stato osservato un raro incrocio tra la ghiandaia blu e verde. Il tutto è avvenuto in Texas e, considerando le denominazioni inglesi, blue e green, gli scienziati l’hanno definita grue jay (ghiandaia grue o, per italianizzarla, “vru”). Potrebbe rappresentare la prova di come i cambiamenti climatici stiano modificando i confini della biodiversità. … Il primo a parlare di questa nuova ghiandaia è stato Brian Stokes, dottorando in ecologia, evoluzione e comportamento presso l’Università del Texas ad Austin. Ecco le sue parole: “A prima vista sembrava una normale ghiandaia blu, ma con delle caratteristiche insolite. Il piumaggio blu intenso, tipico della specie si mescolava a segni facciali neri, quasi identici a quelli della ghiandaia verde”. L’uccello è stato catturato per un breve esame sul campo. I ricercatori hanno così potuto prelevare un campione di sangue, sottoponendolo ad analisi del DNA. Un risultato inequivocabile: un ibrido naturale. È il primo mai documentato tra queste due specie di ghiandaie, separate da circa 7,5 milioni di anni di evoluzione. L’incrocio tra le due ghiandaie non sarebbe stato possibile in passato. Il motivo? Le due specie vivevano infatti in aree geografiche distinte. Oggi, però, qualcosa è cambiato. Stokes ritiene infatti che il riscaldamento climatico e le modifiche del territorio stiano spingendo le ghiandaie verdi verso nord. Nel corso degli ultimi 50-60 anni, le temperature invernali in Texas sono aumentate. Al tempo stesso, le intense gelate si sono ridotte, consentendo alla specie meridionale di espandersi in territori in precedenza troppo freddi. In questa sovrapposizione sarebbe nata la ghiandaia gru. Un concreto segnale di come i cambiamenti climatici possano favorire nuove interazioni tra specie.

Fonte: https://www.libero.it/tecnologia/specie-ibrida-ghiandaia-grue-107348
la luce del giorno scompare all’improvviso a causa di un’eclissi solare, gli altri animali restano comprensibilmente disorientati. Per gli uccelli, in particolare, un’eclissi totale di Sole può essere così destabilizzante da “convincerli” a mettere in atto comportamenti che di solito appartengono all’alba o al tramonto. È quanto ha scoperto un gruppo di ricercatori dell’Università dell’Indiana, guidati da Liz Aguilar, dottoranda in Evoluzione, Ecologia e Comportamento. Lo studio, pubblicato recentemente su Science, ha infatti analizzato per la prima volta e in maniera dettagliata la risposta degli uccelli a un’eclissi totale, quella dell’8 aprile 2024, quando l’ombra della Luna ha attraversato il Nord America da Mazatlán (in Messico) a Terranova (in Canada) in poche ore. E in alcuni dei casi analizzati dagli autori, anche lì dove il fenomeno è durato poco più di quattro minuti, molte specie di uccelli hanno iniziato a cantare come se fosse l’alba o il tramonto. … “È stato come se il cervello degli uccelli, improvvisamente ingannato dal buio, avesse premuto il tasto reset del ritmo circadiano”, hanno spiegato gli autori. Gli uccelli che cantano, come i piccoli passeriformi in particolare, hanno infatti risposto all’eclissi con un picco di vocalizzazioni, seguito da un silenzio simile a quello che precede il tramonto. Per poter arrivare a questa conclusione raccogliendo dati su larga scala, Aguilar e il collega Paul Macklin, ingegnere esperto in Intelligenza Artificiale alla Luddy School of Informatics, hanno sviluppato un’app di citizen science gratuita e appositamente progettata per studiare gli uccelli durante l’eclissi, chiamata SolarBird. L’idea era molto semplice: trasformare migliaia di persone, appassionati e birdwatcher in osservatori del comportamento animale per un giorno. … In poche ore, SolarBird ha raccolto quasi 11.000 osservazioni da oltre 1.700 partecipanti, concentrati lungo la fascia di totalità. … I dati hanno confermato quanto osservato anche dai cittadini: un aumento delle vocalizzazioni nel momento in cui il Sole scompariva, seguito da un brusco silenzio, quasi come se gli uccelli stessero aspettando che la luce tornasse.

Fonte: https://www.fanpage.it/kodami/gli-effetti-di-uneclissi-di-sole-totale-sugli-uccelli-come-la-luce-inganna-il-cervello-e-regola-i-ritmi-naturali/

Siparla di conix e si propone uno standard; ora c’è da chiedersi come arrivarci?
In termini critici ed anche autocritici, bisogna sapere che quello che si diceva prima, me compreso, cioè che il cobalto fosse una mutazione recessiva, era sbagliato. Paolo Corbelletto ci ha spiegato che invece è dominante parziale (Cobalto I.O. n°8/9 del 2022). Quindi i nostri schemi precedenti vanno cassati. Il conix, questo sì, è l’interazione di onice e di cobalto. Tale interazione somma l’effetto diffusivo di entrambe, con un esito molto scuro. Non mi soffermo sulle due mutazioni, già trattate ampiamente in passato. Semmai appare ovvio che i conix dovrebbero essere di due tipi, vale a dire quello a doppio fattore cobalto e quello a singolo fattore cobalto. Purtroppo mancano descrizioni precise sulle differenze fra le due espressioni attinenti al cobalto, singolo o doppio fattore. Mi piacerebbe averne, tuttavia appare ovvio che il doppio fattore debba essere il migliore poiché più accentuato. Lascio ai cultori di questo tipo ulteriori interventi, che sarebbero davvero utili. In questa sede desidero soltanto ricordare la trasmissione indipendente dei due caratteri ed il modo di arrivo al conix, sempre che non ci siano già disponibili soggetti adeguati. Accoppiando un cobalto, a doppio fattore, con un’onice si ottengono cobalto a singolo fattore portatori di onice; se si usasse un singolo fattore cobalto, solo la metà. Accoppiando fra di loro tali soggetti cobalto singolo fattore portatori di
onice, il 25% sono onice e di questo 25%, un 25% (uno su quattro) solo onice, il 50% conix singolo fattore cobalto (due su quattro) ed il 25% conix doppio fattore cobalto (uno su quattro). Sull’intero della prole il 25% del 25% equivale ad 1 su 16 ed il 50% di un 25% equivale sul totale a 2 su 16. Quindi i conix a doppio fattore saranno pochi, solo 1 su 16 (il 6,25%). Non riuscendo a fare la coppia, si potrebbe accoppiare un conix a doppio fattore cobalto con un conix a singolo fattore cobalto, avendo così nella prole il 50% di conix a doppio fattore cobalto. Accoppiando due conix singolo fattore cobalto si avrà il 25% di doppio fattore cobalto. Non molto ma più di uno su sedici.
Per gli amanti dei portatori segnalo che da un cobalto a doppio fattore, portatore di onice, accoppiato con un conix a doppio fattore cobalto, avremmo la metà di cobalto doppio fattore portatori di onice e metà conix a doppio fattore cobalto.
Non mi sembra il caso di andare oltre con gli accoppiamenti ed i loro risultati; ritengo di aver detto l’essenziale, sperando di non aver errato. Si tenga sempre presente che un conix non è un tutt’uno ma un’interazione e che i due caratteri, onice e cobalto, si trasmettono indipendentemente. Sulla novità di ammettere per la prima volta un’interazione fra tipi aggiunti, ritengo che ognuno possa avere la sua opinione, personalmente non sono contrario a questa eccezione.
Giovanni Canali





testo e foto di ALESSANDRO PAPARELLA
L’Associazione Ornitologica Tirreno, con la concessione del “Giardino dell’infanzia” da parte del Comune di Bellizzi, ha nel programma attività sociali: ludiche, sportive, culturali.
Fornito di ampio spazio, di campo di calcio, di voliere per uccelli e piccoli gallinacei ornamentali per l’interazione fra bambini e pennuti, di angolo lettura, di arredi per consentire riunioni varie, di barbecue, ha dato inizio ad un progetto principalmente sociale, oltre che ornitologico, in favore dei bambini, accogliendo giovani e ragazzi e consentendo la socializzazione e, in particolare, l’integrazione

Un progetto principalmente sociale, oltre che ornitologico, in favore dei bambini
fra bambini diversamente abili e bambini normodotati.
Una mattinata di meravigliosa scoperta è ciò che hanno vissuto i piccoli partecipanti, oltre cento, accompagnati da parenti ed amici, alla prima manifesta-
zione ornitologica, dove i bambini hanno potuto avvicinarsi al tavolo degli uccelli e osservare da vicino le numerose specie prima di procedere all’estrazione del premio jolly, costituito da una grossa gabbia piedistallo con una coppia di Calopsitte e di 50 uccellini di vario genere e relative gabbiette. Descrivere l’entusiasmo di ciascun bambino, il suo sorriso quando veniva in possesso dell’uccellino sorteggiato ci ha sorpresi, come anche le numerose domande curiose relative alle specie di uccelli, all’alimentazione, all’adattamento alla gabbietta, se fosse utile fornire dei giochi… domande a cui hanno risposto i nume-





rosi allevatori presenti sodisfacendo le curiosità dei piccoli e trasformando il momento in una esperienza educativa nel mondo degli alati. Il progetto inserito nel programma dell’Associazione Tirreno ha voluto suscitare nei piccoli presenti vivo interesse in una generazione attenta e dedita all’amore per gli animali, uccelli ed altre razze, educando alla cultura dell’ambiente che li ospita e, nel contempo, regalando benessere.


Papa Francesco affermava spesso che i bambini sono un dono per l’umanità, una ricchezza e un segno di speranza e di vita, e che la loro condizione riflette la salute della società. La partecipazione del presidente F.O.I., Avv. Antonio Sposito, ha dato lustro alla manifestazione commentando positivamente le iniziative della A.O.T. ed elogiando questa iniziativa a favore dei bambini, fiducioso che sia l’inizio di una lunga serie.


Ha ringraziato il promotore Mario Procida e tutto il suo gruppo per il lavoro che svolgono nel corso dell’anno per l’A.O.T., condividendo e portando avanti le politiche e l’attività della Federazione Ornicoltori Italiani.
Un grazie di cuore da parte di tutti i numerosi presenti al Presidente Sposito, a tutto il Consiglio direttivo ed ai collaboratori, soci e non, della A.O.T.
Sabato
I NOSTRI LUTTI
20 settembre 2025 improvvisamente e mancato Piero Caprino. Appassionato fin da giovane di canarini di colore che allevava con amore e dedizione. Per 40 anni e stato segretario dell’Associazione A.M.O. di Casale Monferrato dedicando buona parte del suo tempo a gestire le iniziative che nell’arco degli anni sono state svolte. Nessuno si aspettava di ricevere la notizia della sua scomparsa che ha lasciato un gran vuoto in tutti noi. Sicuramente abbiamo perso una colonna portante per l’Associazione e per il Raggruppamento che difficilmente dimenticheremo.
Il Presidente A.M.O. e tutti i soci si stringono con affetto a moglie e figlie… Fai buon viaggio Piero!


testo e foto RICCARDO TESTORI
Lo scorso anno, esattamente Giovedì 1 agosto 2024, c’è stata la terza visita dell’AOT Palermo ai bambini dell’Akuna Matata Onlus, che opera nella borgata di Ciaculli, quartiere alla periferia est di Palermo, in un grande agrumeto sequestrato alla mafia, con la montagna alle spalle ed il mare della Conca d’Oro davanti. Questa Onlus ha tra le sue finalità la “riqualificazione ambientale dei territori urbani periferici, attuazione dei servizi sociali, potenziamento dell’educazione permanente, offrendo ospitalità ed aiuto alle famiglie e organizzando attività ludiche estive e doposcuola pomeridiani invernali”. Una costruzione centrale consente di ospitare più di cento bambini e ragazzi dai 5 ai 14 anni.
Grazie ai contatti, curati dal nostro consigliere Francesco Ciprì, abbiamo trascorso tre giornate con i bambini, nello scorso luglio, ed essi hanno avuto l’opportunità di vedere numerosi cenerini e pappagalli, di ricevere pubblicazioni del Corriere Ornitologico, curato per anni dal nostro ex presidente Gianni Matranga, ed altrettanti numeri di Italia Ornitologica. Ci è mancato, purtroppo, il vecchio giornalino FRIN (attualmente in ristampa, NdR).
Questa è stata la terza volta che ci ha visti immersi in questa piacevole atmosfera creata dalla presenza di tanti piccoli amici, curiosi, attenti, vivaci, con l’intelligenza dei loro grandi occhi, che ci hanno chiesto quando, come

e perché gli uccelli ci offrano colori e canto in mezzo al verde della natura.
Nella foto il momento culminante, con la donazione di un novello di calopsitta, che è subito divenuta la mascotte della Onlus ospitante.
Abbiamo in questa occasione constatato come un bene confiscato alla mafia, privo di forma e fruizione, possa diventare una realtà che offre interessanti spunti per divenire il simbolo tangibile della valorizzazione culturale del territorio (anche l’AOT da vent’anni ha la propria sede dentro un bene confiscato alla mafia) ma è importante anche da parte nostra sottolineare che tanti devono e possono essere gli approcci simili e gli interventi delle nostre Associazioni presso i giovani.

Se riflettiamo, la nostra passione ed attività ornitologica è riservata e specialistica, poco conosciuta, poco pubblicizzate le nostre mostre. La nostra è una passione che quando è vera inizia in gioventù e non ti stanca mai (io sono uno di questi: allevavo a 10 anni nel 1949, mi sono iscritto alla FOI nel 1968 ed ancora oggi sono ancora qui che trasmetto passione ai ragazzi, come se fosse il mio primo giorno). Pertanto, largo ai giovani perché in loro si ripongono le speranze della nostra Federazione. Anche quest’anno, abbiamo invitato i piccoli a visitare la mostra internazionale della Conca d’Oro a Palermo (apertura al pubblico l’8 e il 9 novembre 2025) dove è stato organizzato per loro un concorso a premi per disegni sugli uccelli.

testo di SEBASTIANO PATERNÒ, foto LUIGI CICERO
Introduzione
È venuto il momento di iniziare a trattare d’un uccello, rarissimo, se non sconosciuto nei nostri allevamenti, difficile da vedere, impossibile da trovare. È per tale motivo che nel novembre scorso (2024), a Modena, in occasione della 83ª Esposizione Internazionale della Società Ornitologica Reggiana, nel visitare uno stand molto nutrito e bene allestito con abbondanza d’uccelli provenienti da tutto il mondo, vengo attirato dalla presenza di due esemplari, molto calmi e sereni e molto rari in ornicultura e dalla semplicissima identificazione, data la sagoma tipica, le movenze aggraziate e caratteristiche ed il particolare abito prevalentemente bianco. Erano rari Storni di Bali.
Del resto, era chiaramente specificato, nella cartellina apposta sulla gabbia, il nome della specie, che si trattava di una coppia ed il “quantum” per acquisirli.
Nei tre giorni espositivi, ripassai parecchie volte ad osservarli, senza decidermi, fin quando la domenica vidi un bel cartello sulla gabbia: ceduti! Qualche paio di mesi addietro, un mio caro amico, allevatore/commerciante molto loquace e presente sui social, Luigi Cicero di Scicli, pubblica a sorpresa delle foto della avvenuta riproduzione dello Storno di Bali, con la nascita di tre piccoli. Ecco dov’era finita la coppia!
Tassonomia
È un uccello classificato nella famiglia degli Sturnidae ed è l’unica specie del genere Leucopsar, come classificato nel 1912 dall’Ornitologo Stresemann: Leucopsar rothschildi. È lungo circa 25 cm, con piumaggio completamente




È lungo circa 25 cm, con piumaggio completamente bianco tranne la parte finale di remiganti e timoniere, che risulta nera
bianco tranne la parte finale di remiganti e timoniere, che risulta nera. Attorno agli occhi vi è una “maschera” di pelle nuda di colore blu. Sul capo è presente una caratteristica cresta erettile (foto n.1).
In natura
È presente solo nell’isola di Bali in Indonesia e pare che in natura esistano meno di 100 esemplari. È stato sco-



perto solo nel 1910, con circa meno di 1000 individui presenti a quella data, ma la sottrazione di habitat nell’isola e la voglia di mostrarli in fiere e gabbie artistiche da parte degli allevatori locali sia per i colori tipici, come anche per il canto piacevole, hanno ridotto drasticamente la

È presente solo nell’isola di Bali in Indonesia e pare che in natura esistano meno di 100 esemplari
già misera popolazione in natura, che adesso risulta essere in “pericolo e situazione critica” e sull’orlo dell’estinzione. Fortunatamente, negli zoo di tutto il mondo è stato acquisito ed è presente con progetti di reintroduzione nel loro ambiente naturale, fornendo anche luoghi di nidificazione artificiali in sostituzione delle perdite di cavità naturali. Molti soggetti sono stati reintrodotti nell’isola di Bali con lo scopo di recuperare e mantenere la popolazione nella loro piccola isola indonesiana.
In allevamento
Pur essendo molto vistoso e bello, con quel piumaggio bianco candido, punta delle remiganti e timoniere nere, becco giallo e una piccola maschera blu attorno agli occhi, nei nostri allevamenti non è presente, o me-
glio, non lo era; adesso è stato riprodotto ed è da riportare l’esperienza dell’amico Luigi Cicero, al quale ho chiesto di fornire elementi per altri che volessero iniziare lo stesso programma di allevamento. Ha accettato di buon grado e di seguito ecco le sue esperienze.
Cantano entrambi i sessi. Come tutti gli storni, dovrebbe risultare abbastanza longevo per riuscire a vivere fino ad un quindicennio.
Hanno nidificato, in ampia voliera, in un tronco d’albero scavato artificialmente all’occorrenza. Il nido è stato costruito da entrambi i soggetti, con elementi grossolani, senza materiale raffinato.
Le uova deposte sono state in numero di tre, di colore blu. L’incubazione è durata giorni 13/14 giorni e i piccoli alla nascita si presentavano con carnagione rosea e con ampia apertura buccale (foto n.2), caratteristica di tutti gli Sturnidi.
L’alimentazione dei primissimi giorni è avvenuta con la somministrazione di tarme della farina vive e pinkies congelate, per aggiungere dopo la prima settimana vermi caimani e grilli congelati (foto n.3). Si è avuta la fortuna di trovare anche in compostiera delle tarme di mosca sol-


dato (Hermetia illucens) che si sono dimostrate, per questa specie, un alimento super.
Pur avendo riservato alla nidiata molta cura ed accortezza, un pullo è morto subito dopo la nascita, mentre a un secondo nato si è conficcato un rametto di circa cm 15 dentro l’anello inamovibile impacciandolo nella postura e nelle movenze e, seppure fosse il più piccolino, sopravvisse ancora (foto n.4), ma venne sopraffatto dall’unico restante, che venne regolarmente anellato e accudito dai genitori fino al completo svezzamento (foto n.5).
Certamente, dopo questa prima esperienza, le successive avranno maggior fortuna. Anche se, per allevatori provetti e con parecchio tempo disponibile, sarebbe più fruttuoso l’allevamento a mano dopo il settimo/ottavo giorno di nascita. Vedremo in seguito che sviluppo avrà


questo unico soggetto e come si riuscirà ad incrementare numericamente questa bella e vistosa specie.
Alla fine di questo mese dovrebbe pervenire il Cites di conferma per la nascita regolarmente dichiarata.





testo di ROBERTO BASSO, foto DELL’ARCHIVIODELL’ASSOCIAZIONE A.R.C.A. 113 ECOLOGICO O.D.V.


Vi sarete accorti che, nonostante le ferree restrizioni e divieti che negli ultimi quarant’anni sono stati emanati in Italia relativamente al prelievo degli uccelli silvani, si è assistito a una loro drastica diminuzione e rarefazione, non solo di quelli nidificanti, ma anche, in una visione più ampia, delle masse migratorie che un tempo attraversavano la penisola italiana. E su quest’aspetto gli animalisti, soprattutto quelli fondamentalisti, si sono scatenati, accusando il mondo venatorio o di chi un tempo catturava talune specie vive, per mero diletto di allevarle o detenerle in cattività, di essere la causa scatenante, se non esclusiva, della loro rarefazione. Questo atteggiamento dura ormai da tempo, senza che nessuno si sia
mai preoccupato di analizzarlo in modo più attento, con dei parametri di confronto tra il passato e il presente e in base a una valutazione oggettiva di cause e concause.
Bisogna essere ciechi per non essersi accorti che nell’ultimo ventennio, durante i mesi primaverili ed estivi, per-
Questo atteggiamento dura ormai da tempo, senza che nessun si sia mai preoccupato di analizzarlo
correndo qualunque strada che consenta una percorrenza veloce, i parabrezza delle macchine non si sporcano più a causa della collisione con gli insetti. Quando parliamo di insetti dobbiamo considerare non solo i comuni e volgari moscerini o zanzare, ma coleotteri, odonati, farfalle, imenotteri, ecc. Oggi, quando troviamo imbrattati i parabrezza delle nostre auto, è perché abbiamo parcheggiato in un viale o in posti dove colombacci, colombi torraioli o storni “bombardano” di guano. Mi capita a volte di attraversare zone e ambienti di pianura o di collina che in passato ben conoscevo, in quanto li frequentavo assiduamente, sapendo con precisione l’ubicazione di siepi, boschetti, anche di isolati alberi d’alto fu-

sto. Insomma, aree vocate all’agricoltura intensiva ed estensiva allora mantenevano una biodiversità ambientale, sotto il profilo vegetazionale, di un livello funzionale alle esigenze della catena alimentare. Cito la catena alimentare perché nel mondo, come sappiamo oggi, si conoscono ben oltre 2 milioni di specie di insetti e sicuramente ancora molte sono da scoprire, ma altrettante stanno estinguendosi o scomparendo a causa dell’impoverimento ambientale. Ecco, questa potrebbe essere una delle tante motivazioni per cui i nostri insettivori europei e paleartici stanno rarefacendosi. Queste specie dipendono esclusivamente da un’alimentazione legata ad insetti adulti o in stato larvale di bruchi o loro uova, solitamente deposte tra le fessure delle cortecce degli alberi, tronchi marcescenti o nel terreno.
Non trascuriamo che nel 1978, anche in Italia, venne vietato l’uso del DDT, che sappiamo essere stato una delle cause scatenanti di avvelenamento del suolo ed anche della sua vegetazione e derivante fauna. Anche l’acqua che scorre nei torrenti, nei canali o che si può rinvenire in alcune pozze continua ad essere inquinata da diserbanti, pesticidi o sostanze chimiche; ebbene, i piccoli passeriformi non sanno distinguere se trattasi di acqua che contiene sostanze tossiche o avvelenate e, consumandola, in breve tempo si indeboliscono e periscono.
E allora? La risposta appare semplice e scontata: distruzione degli habitat, ra-

refazione della vegetazione, inquinamento delle acque, diminuzione degli insetti sono da ritenersi potenziale causa della scomparsa di specie animali che dipendono proprio dalla ricchezza della biodiversità dell’ambiente a cui sono legati per l’alimentazione e la loro riproduzione. Possiamo, queste specie di piccoli insettivori, proteggerle quanto vogliamo ma, se non garantiamo loro ogni giorno una quantità di cibo sufficiente per il loro sostentamento e un ambiente in cui poter costruire i loro nidi e allevare i loro piccoli, il rischio della loro futura estinzione è scontata. È vero, un tempo si cacciavano o catturavano, ma se si ha una popolazione di 100 individui e se ne preleva ipoteticamente una quantità pur esagerata del 50%, l’anno dopo, potendosi riprodurre,

ritorneranno di nuovo 100. Esempio semplice, forse banale, ma realistico. Esiste poi un altro grande fattore impattante, che è stato denunciato e provato più volte dagli australiani, ma anche da alcuni edotti naturalisti statunitensi e inglesi, legato al proliferare di gatti domestici inselvatichiti o che vivono in condizioni di semi-libertà; ogni giorno, soprattutto nel periodo legato alle nascite e all’involo dei pulli dai nidi, il loro innato istinto predatorio li vede fare razzia. Un gatto può predare nei mesi, da fine aprile ai primi di agosto, anche 7-8 pulli al giorno ed è stimata una popolazione di gatti in semilibertà in Italia di circa 180.000 individui. E a nulla servono gli schiamazzi disperati degli adulti nidificanti per impedirne la predazione. A ciò va aggiunto il crescente proliferare dei corvidi, anche all’interno dei centri urbani, come gazze, ghiandaie, taccole, cornacchie grigie e in ultimo anche di sempre più numerose colonie di opportunisti gabbiani reali, che proprio in quei mesi riproduttivi si specializzano nella predazione di uova e pulcini.
Non a caso ho citato l’Australia e altri stati dove da anni, a seguito di approfonditi studi, stanno cercando, anche attraverso il varo di severe disposizioni legislative “penali”, il divieto di detenere gatti in semi-libertà al di fuori dei muri abitativi, oltre ad aver legiferato veri e propri piani di eradicazione delle popolazioni di gatti inselvatichiti o semi-domestici per scongiurare l’estinzione dei loro endemici marsupiali, rettili e uccelli.




Eppure in Italia tutto tace, tutto è come se fosse normale e quando qualcuno se ne accorge o necessariamente ne deve parlare, ecco, la colpa è attribuita solamente all’attività venatoria, distraendo così l’opinione pubblica dalle altre cause e concause. Ma si ha idea di
quanti uccelli migratori e non solo durante il giorno e la notte periscono sbattendo contro quel muro di vetri o vetrate che subito dopo i chilometri di spiagge italiane si innalzano verso il cielo? Il riflesso di questi vetri è ogni anno un motivo d’attrazione e di im-
patto per milioni di uccelli, in particolare proprio i piccoli migratori. E poi che dire delle pale eoliche, collocate proprio nei punti più strategici per le migrazioni: i valichi o in quelle vallate dove i venti naturalmente si incanalano? Non dimentichiamo che le pale eoliche svol-







gono questa loro funzione ininterrottamente, giorno e notte, e quando un migratore gli si avvicina a una distanza di 30-40 metri viene risucchiato dal vortice d’aria subendo inevitabili traumi e fratture interni. Badate bene che intorno a queste pale eoliche, nel raggio di diverse centinaia di metri, si rinvengono anche le spoglie di grandi migratori, come cicogne, ardeidi, rapaci diurni e notturni, ma di questo, a parte alcuni coraggiosi e veri naturalisti o ambientalisti, nessuno parla. Va anche detto che le spoglie degli uccelli più piccoli vengono sistematicamente a loro volta predate da abitudinari carnivori come volpi, gatti o opportunisti come ratti, ricci e corvidi. Questi mostri di cemento armato alti decine e decine di metri sono sotto gli occhi di tutti e gli animalisti asseriscono, giustificandoli, che sono l’unico modo, assieme ai pannelli solari, per produrre energia pulita. Non dobbiamo poi trascurare il crescente e incontrollato consumo di territorio selvaggio dovuto alla cementificazione, che sottrae ed elimina suolo, soprattutto nelle zone di pianura, zone umide o boscate. Dai dati complessivi emerge che nel nostro Paese ci sono oggi 8.241 specie e sottospecie vegetali autoctone, di cui 1.702 endemiche (cioè esclusive del territorio italiano), mentre 28 si sono recentemente estinte. Si dovrebbe invece rendere obbligatorio riqualificare tutte quelle costruzioni in disuso o obsolete, soprattutto i grandi complessi pubblici come scuole, uffici, ospedali, su cui imple-

mentare la messa in posa di pannelli solari sui tetti. Lo stesso dicasi per i sempre più ampi capannoni delle zone industriali.
E cosa dire, poi, dell’aumento esponenziale dei collegamenti stradali, sempre più scorrevoli e quindi veloci, che anch’essi causano, oltre che la sottrazione di ambiente, anche un pericolo di collisione con gli animali stessi? Ultimamente è esplosa la moda di fare piste ciclabili, sicuramente non inquinanti, ma molte vengono realizzate lungo i corsi d’acqua, sugli argini di fiumi e canali, andando così a eliminare l’ambiente vegetazionale ripariale e creando un disturbo a quelle specie che nidificano proprio nella vegetazione lungo gli argini dei corsi d’acqua. Si ribadisce che l’inquinamento del terreno e delle acque può rivelarsi fatale per la sopravvivenza di quelle specie che ne dipendono.
Vengono dallo Stato devoluti ogni anno milioni di euro per la gestione di centri recupero di fauna selvatica. Provengo da un’esperienza ultradecennale e diretta di gestione nei lontani anni Ottanta/Novanta di queste strutture e oggi le reputo inutili al fine della tutela e conservazione della fauna selvatica, che vede, dopo la loro degenza e eventuali ed opportune cure, una parte veramente irrisoria di individui che, rimessi in natura, possano continuare ad adempiere alle loro funzioni vitali e riproduttive. Mentre quello che bisognerebbe fare è creare centri pubblici o privati preposti alla riproduzione e
reintroduzione in natura di specie a rischio di estinzione.
In Italia abbiamo avuto degli esempi di naturalisti e strutture che si sono veramente distinti per i risultati ottenuti. Pensiamo al naturalista Fabio Perco, che negli anni Ottanta-Novanta ha creato i centri di riproduzione e immissione delle cicogne bianche, che oggi ormai sappiamo essere diffuse e nidificanti in molte regioni italiane. Pensiamo al suo progetto sull’oca grigia o sull’oca selvatica, che oggi vede questa specie nidificare nel nord Italia con centinaia e centinaia di coppie; pensiamo anche al Centro Grifone di Cornino (UD), che oggi rappresenta la colonia nidificante più importante sulle Alpi e il suo carnaio attira e nutre ogni anno molti esemplari di rapaci rari e accidentali. Non dimentichiamo, poi, il Centro Cicogne di Racconigi (CN), fortemente voluto da Bruno Vaschetto, che fu ed è ancora oggi un importante centro di riproduzione di rari anatidi, come il gobbo rugginoso. Ed infine, ma non certo per importanza, il Parco Natura Viva di Bussolengo (VR), fondato e diretto per molti anni da Cesare Avesani, che ha visto la stabulazione e riproduzione di decine di rare specie animali, non solo europee.
Ebbene, ancora una volta non si può non riconoscere che la competenza e la passione di allevatori hanno consentito l’acquisizione di importanti nozioni etologiche e un importante contributo per la tutela e la salvezza di specie rare e a rischio di estinzione.
La C.T.N. Ondulati & altri Psittaciformi ha riscontrato che vi sono difficoltà nel reperire le informazioni basilari per l’allevamento ed esposizione degli uccelli.
Per superare questi ostacoli è stata ideata una piattaforma web che permette una facile e rapida consultazione ed acquisizione di informazioni fondamentali per il nostro hobby.
Per accedere alla piattaforma non è necessario registrarsi; è sufficiente con uno smartphone digitare: http://www.ctnop.it

1.La piattaforma che appare è costituita da cinque sezioni con menu a tendina per effettuare le ricerche:
2.Ricerca Categorie a Concorso;
3.Ricerca anelli 2026;
4.Elenco documenti propedeutici alle esposizioni;
5.Corsi per Allevatori.
6.Corso per Giudici.

1.Ricerca categorie a concorso
Il primo step di questa sezione definisce:
-Ondulati di colore, -Ondulati di F&P, -Psittaciformi.
Il secondo definisce le Categorie a concorso ufficiali FOI previste nelle Mostre:
-Mostre tipo A (cat. minime), -Mostre tipo B (cat. ampliate), -Campionati Regionali e Campionato Italiano.
Il terzo permette la ricerca per:
-Numero di Categoria a concorso; -Descrizione della Categoria a concorso;
-Per fenotipo del soggetto (mutazione e/o colore riconosciuti a Concorso).
È importante verificare che la mostra dove desideriamo esporre adotti una delle Categorie ufficiali FOI (foto 2) altrimenti il codice della categoria risulta errato.
Il risultato finale sarà una schermata (foto 3) in cui troveremo tutte le informazioni necessarie per esporre.


2.Ricerca anelli
In questa sezione è sufficiente inserire il nome della specie per avere tipologia e misure (in millimetri) raccomandate per gli anelli da utilizzare. Per evitare errori, si consiglia di effettuare la ricerca digitando il nome latino della specie.
La schermata (foto 4) riporterà le informazioni necessarie anche per ordinare gli anelli da parte delle Associazioni.



3.Elenco documenti propedeutici alle esposizioni
In questa sezione (foto 5)troviamo tutti i documenti (in vigore) che possono servire per avere una visione d’insieme più chiara sulle attività espositive e si suddividono in:
-Standard descrittivi Ondulati (2)
-Standard descrittivi Psittaciformi (21)
-Categorie a concorso FOI (3)

-Documenti per mostre (14)
Questa sezione è da visionare per una corretta compilazione della scheda di iscrizione nelle mostre FOI.
4.Corso per Allevatori
In questa sezione (in allestimento) stiamo predisponendo dei corsi destinati agli allevatori-espositori per migliorarne la preparazione tecnica

Nella tendina che si apre cliccare “Aggiungi a schermata home”

A questo punto sullo smartphone comparirà l’icona CTNOP
5.Corso per Giudici
Questa sezione è dedicata esclusivamente a Giudici ed Allievi-Giudici di questa Specializzazione.
Importante: è possibile creare l’icona sullo smartphone per un richiamo più veloce dell’applicazione. Digitando: https://www.ctnop.it appare una schermata (foto 6)
Questa applicazione è gratuita e destinata ad Associazioni, Allevatori, Giudici e addetti ai lavori. Saranno graditi eventuali suggerimenti per migliorare ulteriormente la piattaforma e renderla sempre aggiornata e più performante. Commissione Tecnica Nazionale Ondulati & altri Psittaciformi E-mail: ctnondulatiepsittacidi @gmail.com

testo di SERGIO PALMA, foto AUTORIVARI
Il termine exposoma si riferisce all’insieme delle esposizioni ambientali a cui gli individui sono sottoposti nel corso della vita. Questo concetto è stato introdotto per comprendere meglio come le esposizioni ambientali, che includono fattori come inquinamento, dieta, stile di vita e condizioni sociali, possano influenzare la salute e il benessere.
L’exposoma si differenzia dal genoma, che rappresenta il patrimonio genetico di un individuo, poiché si concentra sulle influenze esterne e sulle interazioni tra ambiente e genetica. Negli ultimi anni, l’interesse per il benessere animale ha portato a una crescente attenzione verso gli uccelli da gabbia e da voliera. Spesso considerati semplici animali domestici, vivono in ambienti che possono influenzare significativamente la loro salute. L’exposoma, nel nostro caso, offre una nuova prospettiva per comprendere le interazioni tra gli uccelli e il loro ambiente. Qui si vuole esplorare l’exposoma degli uccelli da gabbia e da voliera, analizzando i fattori ambientali che influenzano il loro benessere. Capire l’exposoma può aiutare gli allevatori a comprendere meglio le interazioni tra ambiente e genetica e a sviluppare strategie più efficaci per la prevenzione delle malattie. L’exposoma aiuta a comprendere come le diverse esposizioni ambientali influenzino la salute e il comportamento degli animali. Questo è fondamentale per identificare fattori di stress che possono compromettere il benessere.
Analizzando l’exposoma, si possono in-


dividuare fattori di rischio specifici legati all’ambiente in cui gli animali vivono, come la qualità dell’aria, la presenza di sostanze tossiche o pratiche di gestione inadeguate. Con una migliore comprensione delle esposizioni che influiscono sul benessere animale, è possibile sviluppare strategie più efficaci per migliorare le condizioni di vita degli animali, riducendo lo stress e promuovendo la salute. L’approccio dell’exposoma incoraggia l’integrazione tra diverse discipline scientifiche, come la veterinaria, l’ecologia e la biologia molecolare, per affrontare in modo olistico le questioni relative al benessere animale.
I dati sull’exposoma possono informare
le politiche pubbliche e le normative riguardanti il trattamento degli animali, contribuendo a creare standard più elevati per il loro benessere. L’approccio all’exposoma consente anche una ricerca più personalizzata sul benessere animale, considerando le specifiche condizioni ambientali e individuali degli animali in studio. L’exposoma umano e l’exposoma animale si riferiscono entrambi all’insieme delle esposizioni ambientali che un organismo subisce nel corso della sua vita, ma ci sono alcune differenze significative tra i due concetti, legate principalmente alle specificità biologiche, ecologiche e comportamentali degli esseri umani verso i consimili e degli umani verso gli animali.

Ecco alcune delle principali. La variabilità biologica è molto più ampia tra le diverse specie animali. Ogni specie ha adattamenti unici che influenzano come rispondono alle esposizioni ambientali. Ad esempio, gli animali da allevamento possono avere esigenze nutrizionali e comportamentali molto diverse rispetto agli animali selvatici. Lo spazio vitale e le dimensioni della gabbia sono aspetti cruciali per il benessere degli animali, in particolare per quelli domestici e da allevamento.
Ecco alcuni punti chiave riguardanti questi concetti.
Spazio Vitale: lo spazio vitale si riferisce all’area in cui un animale può muoversi liberamente, esprimere comportamenti naturali e interagire con l’ambiente circostante.
Comportamento Naturale: gli animali e gli uccelli in particolare, hanno bisogno di spazio sufficiente per esprimere comportamenti naturali come volare, saltare, esplorare e socializzare. La mancanza di spazio può portare a stress, ansia e comportamenti anomali, quali la autodeplumazione o apatia o anche portare al cannibalismo o, ancora, a comportamenti simili a quello che negli umani è definito “bullismo”. Varietà delle Esigenze: le esigenze di spazio variano notevolmente tra le diverse specie e razze. Ad esempio, un uccello di grande taglia avrà bisogno di più spazio rispetto a un soggetto di piccola taglia, quale il canarino o altri piccoli volatili. Esistono normative e linee guida che stabiliscono le dimensioni minime delle gabbie per diverse specie di volatili, ma riferite solo ad avicoli da reddito. Esse sono spesso basate su studi scientifici che valutano il benessere animale. Ma alla luce delle attuali normative, dopo diverse ricerche su banche dati ministeriali, non risulta alcuna disposizione di legge che preveda specificamente quale sia lo spazio vitale per gli uccelli da gabbia e da voliera o da affezione che dir si voglia.
(La FOI ha redatto un Disciplinare di Autocontrollo relativo alla protezione durante l’allevamento, l’esposizione, la movimentazione sportiva e non commerciale di uccelli d’affezione, da

Fonte: www.pexels.com, autore:SkylerEwing
gabbia e da voliera – pubblicato sul sito www.foi.it – n.d.r.)
Il 15 ottobre 1978, presso la sede dell’UNESCO a Parigi, ci fu la proclamazione della Dichiarazione Universale dei Diritti dell’Animale, il primo provvedimento internazionale tendente ad educare l’uomo al rispetto di ogni forma di vita. Da allora, nel mondo occidentale, si sono moltiplicate le disposizioni normative per il benessere degli animali. Gli anni ’70 hanno visto in particolare l’Europa avviare un percorso culturale e legislativo in questa direzione.
Il benessere in relazione agli animali può essere definito come “lo stato di completa sanità fisica e mentale che consente all’animale di vivere in armonia con il suo ambiente” (definizione OMS/Hughes, 1976). Per garantire questo è necessario che vengano assicurati almeno i bisogni essenziali, individuati nelle cinque libertà contenute nel Brambell Report del 1965. Anche il
La variabilità biologica è molto più ampia tra le diverse specie animali

Consiglio d’Europa ha rivolto la sua attenzione alla protezione degli animali siglando numerose convenzioni per la loro tutela (animali da compagnia, trasporto, allevamento, macellazione, sperimentazione ecc.) Le normative possono essere di due tipi: “orizzontali”, che definiscono gli standard minimi obbligatori per la protezione di tutte le specie allevate, o “verticali”, che definiscono le prescrizioni specifiche minime solo per determinate specie o categorie di animali di allevamento.
1.Libertà dalla sete, dalla fame e dalla cattiva nutrizione. Questo primo punto riguarda la qualità, la quantità e la frequenza dei pasti dati agli animali, che devono essere stabilite in base alla fisiologia, all’età, al sesso e alle esigenze etologiche: soltanto tenendo conto di questi aspetti, la dieta degli animali sarà adeguata e bilanciata.
2.Libertà di avere un ambiente fisico adeguato. Ogni animale ha il diritto di vivere in un ambiente adeguato in termini di spazio e di condizioni. Negli allevamenti, i contenitori dovrebbero essere accoglienti, puliti, areati e luminosi, affinché non siano fonte di alcun tipo di disagio per l’animale. Inoltre, lo spazio deve essere tale affinché gli animali pos-

sano muoversi agevolmente e allestito in maniera che possano trovare il luogo giusto per il riposo notturno.
3.Libertà dal dolore, dalle ferite, dalle malattie. Quando prevenire non è possibile, è fondamentale che il dolore degli animali venga valutato in modo approfondito per ottenere una diagnosi precisa e per predisporre le cure adeguate. Ignorare o sottovalutare il malessere fisico di un soggetto non significa soltanto costringerlo a un’ingiusta sofferenza, ma anche determinare rischi per l’incolumità degli altri uccelli e delle persone. Nel nostro ambiente i trattamenti preventivi a base di antibiotici sarebbero da evitare; quelli curativi, invece, sono limitati e, in caso di necessità, avvengono sotto controllo veterinario.
4.Libertà di manifestare le caratteristiche comportamentali. L’animale deve essere libero di manife-

Agli animali deve essere fornita una alimentazione sana, adatta alla loro età e in quantità sufficiente ai loro fabbisogni nutrizionali
stimoli che potrebbero provocare stress, paura e altre emozioni negative e cercando di prevenirli. Agli animali deve essere fornita una alimentazione sana, adatta alla loro età e in quantità sufficiente ai loro fabbisogni nutrizionali. La circolazione dell’aria, quantità di polveri, temperatura, umidità relativa e concentrazione di gas devono essere mantenute entro limiti non dannosi per gli animali:
stare il proprio comportamento di specie. È la libertà più complessa e sfaccettata, perché include molti aspetti della vita dell’animale, come il concepimento in libertà, lo svezzamento naturale, i pascoli naturali e l’interazione con i simili.
5.Libertà dalla paura e dal disagio. Avere a cuore il benessere dei soggetti allevati significa prestare attenzione anche alla loro condizione psicologica, individuando eventi e
Italia Ornitologica è ora disponibile anche in edizione digitale, consultabile da smartphone, tablet e computer.
Tutti gli iscritti alla Federazione Ornicoltori Italiani possono accedere a INTRANET FOI per visualizzare articoli e immagini in una nuova e più agevole modalità.

L’evoluzione di Italia Ornitologica continua… in esclusiva per gli allevatori FOI https://intranet.foi.it/
•temperatura ottimale da 10 a 35 gradi
•Umidità dell’aria < a 80%
•Polveri TPS < a 10 mg / m3
•Velocità dell’aria > a 0.6 m/sec. < a 6 m/sec.
•Illuminazione, naturale o artificiale, che deve garantire il giusto periodo di riposo (8 ore). A ragion di logica, una gabbia deve essere sufficientemente grande da consentire all’animale di muoversi liberamente, senza limitazioni nello svolgere attività na-




turali. Per gli uccelli, la larghezza della gabbia è particolarmente importante per consentire il volo orizzontale. L’exposoma nel canarino allevato in ambiente controllato si riferisce all’insieme delle esposizioni ambientali e alle condizioni di vita che influenzano la salute come, oltre alla dimensione, anche la pulizia della gabbia, la qualità dell’aria, la temperatura e l’umidità. Un ambiente ben mantenuto e spazioso favorisce il benessere dell’animale.
L’alimentazione è cruciale per la salute del canarino. Una dieta equilibrata che include semi, frutta, verdura e integratori è essenziale per prevenire malattie e garantire una crescita sana. Fattori come rumori eccessivi, cambiamenti improvvisi nell’ambiente o la presenza di predatori possono influenzare il livello di stress del canarino. Un ambiente tranquillo e prevedibile è importante per il loro benessere. L’uso di prodotti chimici per la pulizia, pesticidi o fumi tossici, o lo smodato e inopportuno uso di medicinali possono avere effetti negativi sulla salute e quindi sulle performances dei canarini. È fondamentale utilizzare prodotti sicuri e mantenere un ambiente privo di sostanze nocive. L’interazione tra exposoma e mutazioni nel canarino è un argomento affascinante, che esplora come le esposizioni ambientali possano influenzare non solo la salute e il benessere degli uccelli, ma anche le loro caratteristiche genetiche nel tempo.
Alcuni punti chiave su questa interazione: esposizioni ambientali, come sostanze chimiche tossiche, inquinamento, radiazioni e stress possono influenzare il DNA degli organismi, logicamente anche nel canarino. In ambienti protetti, quali i nostri allevamenti, tutto sta nella mano dell’uomo che guida la selezione e possiamo certificare che lo fa anche per l’exposoma del canarino. Nel contesto dell’allevamento di canarini, le mutazioni possono essere selezionate in base alle preferenze degli allevatori. Se un canarino presenta una mutazione che conferisce un colore o un canto particolarmente desiderabile, gli allevatori possono scegliere di riprodurlo. Tutta-
Una dieta equilibrata che include semi, frutta, verdura e integratori è essenziale per prevenire malattie e garantire una crescita sana
via, se l’exposoma non è ottimale (ad esempio, se l’animale è esposto a stress o a una dieta inadeguata), ciò potrebbe influenzare negativamente l’espressione di queste mutazioni, portando a problemi di salute, con degenerazioni riproduttive dovute ad una riduzione della vitalità. Le mutazioni possono anche conferire ai canarini una maggiore resilienza a fattori ambientali avversi. Ad esempio, alcune mutazioni potrebbero rendere un canarino più resistente a malattie o a condizioni climatiche estreme. Immaginiamo quegli allevamenti posti su paralleli completamenti diversi, con una differenza ambientale molto marcata. Tuttavia, se l’exposoma ècaratterizzato da stress cronico o esposizione a tossine, anche le mutazioni favorevoli potrebbero non essere sufficienti a garantire la salute e il benessere dell’animale.
Le mutazioni che si verificano in risposta a fattori ambientali possono essere trasmesse alle generazioni successive. Questo significa che se un canarino sviluppa una mutazione a causa di un’esposizione ambientale, i suoi discendenti potrebbero ereditare questa mutazione. Tuttavia, l’effetto dell’exposoma sui discendenti dipenderà anche dalle condizioni ambientali in cui verranno allevati. La comprensione dell’interazione tra exposoma e mutazioni nei canarini richiede ulteriori ricerche. Monitorare le condizioni ambientali e le mutazioni genetiche può fornire informazioni preziose su come migliorare le pratiche di allevamento e garantire il benessere degli uccelli. L’analisi genetica combinata con la valutazione delle esposizioni ambientali può aiutare a identificare le migliori strategie per la salute e la riproduzione degli uccelli. In sintesi, l’interazione tra exposoma e mutazioni nei canarini è complessa e multifattoriale. Comprendere come questi due aspetti si influenzino reciprocamente sarebbe fondamentale per migliorare le pratiche di allevamento e garantire la salute e il benessere di questi affascinanti uccelli. Comprendere e gestire questi fattori è fondamentale per garantire che i canarini vivano una vita sana e felice in ambiente controllato.



testo e foto di
DANIELA FRESU
La mattinata del 24 maggio, l’Associazione Ornitologica Sarda (AOS) ha avuto il grande piacere di varcare le porte del centro socio sanitario “Don Orione” di Selargius, per una speciale seduta di Pet Therapy che ha lasciato un segno profondo nei cuori di tutti i partecipanti.
Con noi, come sempre, i veri protagonisti: i nostri amati volatili. Le Calopsitte docili e curiose, hanno saputo conquistare gli anziani con il loro approccio affettuoso e la loro dolcezza. I canarini, con il loro canto melodioso, e i nostri piccoli esotici dai mille colori, veri gioielli viventi, hanno creato un’atmosfera serena e gioiosa, che

I canarini, con il loro canto melodioso, e i nostri piccoli esotici dai mille colori, veri gioielli viventi, hanno creato
un’atmosfera serena e gioiosa
ha illuminato il volto dei tanti ospiti della struttura.
Fin dai primi momenti, abbiamo per-

cepito l’attenzione e la partecipazione attiva dei residenti: sguardi pieni di meraviglia, mani tese con delicatezza, domande curiose, racconti del passato che riaffioravano. La presenza dei nostri amici piumosi ha stimolato la conversazione, attivando processi cognitivi fondamentali, soprattutto in persone affette da lievi disturbi della memoria o da forme più avanzate di decadimento cognitivo. La Pet Therapy non è solo un momento di svago, è una vera e propria forma di supporto psicologico che esalta la relazione con gli animali per favorire il benessere della persona. Gli uccelli, in particolare, riescono ad avvicinare con dolcezza anche i più


restii: il loro canto rilassante, il piumaggio morbido e variopinto, i movimenti curiosi attraggono l’attenzione, stimolano i sensi e risvegliano emozioni. Per noi volontari dell’AOS è stata un’esperienza toccante. Vedere il sorriso sul volto degli ospiti, ascoltare i loro racconti di quando da giovani avevano canarini o pappagallini sul davanzale, ha reso questa giornata un momento di condivisione autentica. Un ringraziamento speciale va a tutto il personale del centro socio sanitario
“Don Orione”: alla direzione, agli educatori, agli infermieri, agli OSS e a chi quotidianamente si


prende cura con passione e dedizione degli ospiti. La loro disponibilità, la loro organizzazione impeccabile e la loro gentilezza hanno reso possibile lo svolgersi dell’attività in un clima sereno, accogliente e sicuro.
Siamo convinti che l’unione tra la dimensione umana e quella animale abbia un potere terapeutico che non smette mai di sorprenderci.
Concludiamo, con una promessa: torneremo presto a far volare la gioia, con le nostre piume colorate e il nostro entusiasmo, perché ogni sorriso guadagnato vale più di mille parole.





Guest star: i canarini
Albergo G. 9/10 64
Fenotipo bianco: recessivo vs dominante 1ª p Alfonzetti M. 1/2 5
Fenotipo bianco: recessivo vs dominante 2ª p Alfonzetti M. 3/4 35
Urucum: primato della cromia rossa 1ª p Alfonzetti M. 7/8 5
Urucum: il lato oscuro 2ª p Alfonzetti M. 9/10 27
Cromia nera: divagazioni sulla struttura ottica
Argomenti a tema
Alfonzetti M. 11/12 5
Annaloro G. 3/4 64
Riflessioni ornitologiche e divulgazione Ass. Orn. Maceratese 1/2 62
Senso di appartenenza (e logo della F.O.I.)
L’estinzione del Chiurlottello, verità taciute
Passera lagia, il declino di una Specie
Badalamenti F. 11/12 3
Basso R. 5/6 47
Basso R. 9/10 41 Perché diminuiscono i piccoli
uccelli insettivori e granivori?
Le foto scattate dagli allevatori
Colore del piumaggio nei Canarini Arricciati
Razza Rheinlander - anellino tipo Y (nuova tipologia di anello inamovibile F.O.I.)
Incontri del Collegio su Malinois, Harz e Timbrado
Il Collegio di Specializzazione EFI: stato dell’arte
Nuove nomenclature
I 40 anni dell’A.O.N.
Allevare il Crociere (Loxia curvirostra)
L’utilità dell’allevamento
Considerazioni sulla varietà
Stranezze
Errori da non dimenticare
Gusti da educare
Particolari da osservare
Pezzati, macchiati e struttura
A scuola con gli uccellini
L’Ornitologia che ci piace
Nel cuore del verde: “Il Bosco dei Bimbi” incontra gli amici alati
Le più pericolose malattie degli allevamenti di uccelli
Cardellino Giada
Il Jabot del Benacus
Una sentenza vale più di mille falsità
Italian Gloster Society
Cronache dal M.O.C.
Solo cantori di qualità
Basso R. 11/12 52
Buzzi A. 1/2 28
C.T.N. C.F.P.A. 9/10 18
C.T.N. C.F.P.L. 7/8 28
C.T.N. Canarini da Canto 5/6 30
C.T.N. E.F.I. 11/12 26
C.T.N. OeaP. 3/4 23
Campisi G. 5/6 53
Canale S. 7/8 11
Canali G. 1/2 3
Canali G. 1/2 33
Canali G. 3/4 7
Canali G. 5/6 21
Canali G. 7/8 3
Canali G. 9/10 5
Canali G. 11/12 21
Candioli M. 3/4 50
Carboni E. 9/10 53
Casati F. 7/8 52
Cattarossi D. 11/12 37
Ciraudo F. 3/4 31
Corsa G. e Mollo L. 1/2 11
Crovace D. 3/4 3
De Vita A. 1/2 29
De Vita A. 7/8 39
Di Giorgio F. 9/10 20
Canarini da Canto Di Giorgio F. 11/12 34
Il meraviglioso mondo dei Canarini a Cesena Early A. 5/6 38
Un evento di tutto rispetto
Esbardo F. 1/2 48 Giallo, arancione e rosso… Faggiano F., Olgiati S. dall’ipotesi alla conferma e Club Diamante
La Tortora dal collare domestica
Il Lucherino ventre giallo
Un volo di emozioni: Pet Therapy con l’A.O.S.
Ornitologia e giovani
Nella città della Musica risuonano
Codalunga e Poephila 3/4 13
Faggiano F., Rallo V. e collaboratori 1/2 15
Formisano F. 3/4 51
Fresu D. 11/12 62
Gabriele R. 9/10 38
Gabriele R., Gabriele S. i canti dei canarini Malinois Waterslager e Puglisi R. 3/4 42
Aggiornamento tecnico - Canarini di Forma Gatti L.e Posizione Arricciati
C.T.N. C.F.P.A. 1/2 26
Le foto scattate dagli allevatori
Giordanengo N. 3/4 34
Assemblea F.O.I. 2025 Iannuccilli G. 5/6 3
Settembre, si riparte! Iannuccilli G. 9/10 3
Plumofagia nell’allevamento
della Specie Serinus canaria
Le sottospecie Carduelis carduelis
presenti in Calabria
Leone P. 3/4 27
Leone P. 7/8 47
Ancora un successo a LancianoMaione D. 3/4 46
Italia Ornitologica è (già) diventato bimestrale Marino G. e Faraone G.9/10 60
Esperienze ornitologiche a confronto Martone G. 5/6 42
La carota selvatica Mengacci P. 1/2 56
Centinodia (Scurgiòla o Curzòla) Mengacci P. 5/6 32
Coriandolo (Coriandrum sativum) Mengacci P. 7/8 31
L’Origano comune (Origanum vulgare) Mengacci P. 9/10 47
Epifania a Caltanissetta Miccichè M. G. 9/10 62
Hieronymus Bosch e il Cardellino Mortaruolo I. 9/10 33
Il Diamante di Kittlitz Erythrura trichroa (Kittlitz, 1835) Mortaruolo I. 7/8 17
Le foto scattate dagli allevatori Muraro F. 9/10 40
Dorso chiaro mascherato o… altro? Olgiati S. 5/6 15
Diamante quadricolore x Passero del Giappone: dal mito alla realtà Olgiati S. 11/12 11
Master sul Canarino Salentino Palma S. 3/4 20
Connessi o no? Palma S. 5/6 57
Exposoma (Esposizione ambientale) Palma S. 11/12 58 Manifestazione a Bellizzi Paparella A. 11/12 46
Dissertazioni sul Fanello e standard proposto Paternò S. 3/4 47
Il Codirossone, questo sconosciuto Paternò S. 7/8 55
Ibridazioni nel genere Monticola Paternò S. 9/10 11
Lo Storno di Bali Paternò S. 11/12 49
Il confronto per accrescere la selezione Pellegrino P. L. 5/6 52
Incontro a Nordest con il Presidente della F.O.I. Pindozzi T. 9/10 23
Le foto scattate dagli allevatori Pitasi D. 11/12 25
Un parere sul nero e bruno opale Ranaldi A. 5/6 64
Ornicoltori al Salone Internazionale del Libro Redazione I.O. 9/10 59
Un allevamento a 360 gradi Rossi P. 1/2 43
Gli ibridi - Allevare opere d’arte Rossi P. 3/4 58
Il Parrocchetto dal collare Rossi P. 11/12 15
Il Verzellino mutato: chimera o realtà? Rossi P. e Mondragon I. H. 5/6 7
La consacrazione di Fringillia-Valconca Russo P. 3/4 60
“Aria vecchia” a Psittacus&Co Savini L. 1/2 39
Le foto scattate dagli allevatori
La Ghiandaia marina
Il Rampichino comune Cethia brachydactyla
Lo Scricciolo
Il Conix
Nel Sociale il futuro della F.O.I.
Le foto scattate dagli allevatori
L’importanza dei posatoi per i pappagalli
Consigli per l’allevamento dei pappagalli
Stenico C. 5/6 46
Tessariol D. 1/2 50
Tessariol D. 9/10 55
Tessariol D. 11/12 29
Testori R. 5/6 62
Testori R. 11/12 48
Vicidomini D. 7/8 46
Zamora Padrón R. 1/2 23
Zamora Padrón R. 3/4 44
Gestione durante la stagione riproduttiva Zamora Padrón R. 5/6 27
L’alimentazione è importante
nella biologia dei pappagalli
Spazio, Competizione e Stimolazione
Svezzamento negli psittacidi, una bella sfida
Border - storia di un’amicizia
Zamora Padrón R. 7/8 25
Zamora Padrón R. 9/10 15
Zamora Padrón R. 11/12 41
Zanichelli M. 3/4 59


















